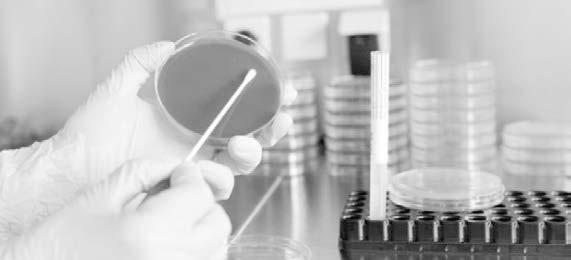

EL HERALDO DE MARTÍNEZ



Veracruz

Se necesitan especialistas

![]()



Veracruz

Se necesitan especialistas

De la Consulta Infantil y Juvenil 2024
BRENDA PÉREZ AGUILAR
MARTÍNEZ DE LA TORRE, VER. -
Realiza el Instituto Nacional Electoral los últimos preparativos para la entrega de los resultados de la Consulta Infantil y Juvenil 2024 a directores de escuelas, esto a fin de que conozca cuál fue la opinión de sus alumnos en dicho ejercicio democrático.
Marcela Vaquero Hernández, Capacitación Electoral y Educación Cívica en la 07 Junta Distrital del INE en este municipio, explicó, que ya están los resultados de la consulta y hay una página en internet en donde la población los puede consultar de manera directa, con el objetivo de que puedan conocer cuál fue la opinión de las niñas y los adolescentes.
Pero, además, el INE entregará estos resultados a los directores de las escuelas en cuánto inicie el nuevo ciclo escolar para que puedan tomar acciones tomando como base la opinión de los alumnos en esta Consulta Infantil Juvenil.
Los temas que se abordaron en la Consulta Infantil y Juvenil, recordó, fueron espacios comunitarios seguros, el cuidado del planeta y la prevención de las adicciones.
Pero hay respuestas diversas de los niños y jóvenes, debido a su rango de edad.
Para finalizar comentó, que las escuelas tendrán que emprender acciones a favor de los y adolescentes en base a estos resultados.

Presidente del Consejo Editorial Dr. Rubén Pabello Rojas
Director General Ing. Stalin Sánchez Macías
Primera Sección
Lunes 11 de Agosto de 2025

Hasta un 30% podría aumentar precios la lista de útiles escolares
MIGUEL BAUTISTA
MARTÍNEZ DE LA TORRE, VER. -
En comparación con el año pasado, el regreso a clases del ciclo escolar 2025–2026, que inicia el lunes 1 de septiembre, podría implicar un gasto considerable para las familias.
Ernesto De Jesús, padre de familia de una telesecundaria, dijo que al consultar en algunos comercios del municipio se encontró que surtir únicamente la lista de útiles escolares tiene un costo promedio que
Gerente administrativo L.C. Laura Ortiz Torres
oscila entre 800 y mil 200 pesos por alumno, sin incluir uniformes, mochilas ni calzado.
El tutor, mencionó que esto significa un duro golpe al bolsillo de las personas, ya que aumento hasta 30% más que el año pasado, ya que el costo de la lista de útiles es el gasto más fuerte, Pero no sé incluyen uniformes o los materiales especializados que se piden en este nivel.
Explicó que, además, la calidad o marca de los productos implica una diferencia en precios, ya que este es otro tema que toman mucho en
Gerente de Marketing L.C. Laura Ortiz Torres
Subdirector Sergio Guillén Fernández Jefe de Talleres Gildardo Daniel Flores
cuenta, siendo los más demandados los de menor costo económico, siendo incluso en el caso de los zapatos escolares, que los modelos más económicos se pueden encontrar desde 300 pesos, pero algunos pueden superar los mil pesos fácilmente. De acuerdo a su experiencia, indicó que la estrategia de las familias ante el impacto económico que representa el regreso a clases es el reciclaje de útiles de ciclos anteriores en buen estado y la compra escalonada de la lista semanas antes del regreso a clases.
HERALDO DE MARTINEZ es una publicación diaria de lunes a sábado. Lunes 11 de Agosto de 2025 | Año 7 | No. 2291 | Editor responsable Ing. Eduardo Sánchez Macías. Número de certificado de Reserva de Derecho al Uso Exclusivo del Titulo 04-2017-090412182000-101. Certificado de Licitud 17081. Certificado de Licitud de Contenido 17081. Domicilio de la publicación, impreso y distribuido por Empresas Franes, S.A. de C.V., con domicilio en Boulevard Rafael Martínez de la
Fax 324-85-47
MIGUEL BAUTISTA
MARTÍNEZ DE LA TORRE, VER. -
La cardiología es una de las especialidades de mayor demanda en los centros hospitalarios de la región, por lo que, sin duda alguna, hoy en día y, sobre todo, ante el aumento creciente en el mundo desarrollado de la enfermedad coronaria, la cardiología se ha convertido quizás en la especialidad médica de mayor demanda, tanto en relación con las medidas de diagnóstico y terapéuticas como, principalmente, la prevención.
Eva Pazos, especialista del área de enfermería, opinó que es necesario que existan dichos especialistas en algunas zonas, ya que ha aumentado la causa de mortalidad por los padecimientos coronarios en todo el distrito, y es una especialidad con la que no cuentan los hospitales públicos, y los
Protección y precios justos se deben incluir en la Ley
Citrícola
ÁLVARO GUERRERO
SAN RAFAEL, VER. -
En la propuesta de la ley citrícola para el Estado de Veracruz se debe incluir la protección y la garantizar un precio justo y elevado del limón persa para los productores, opinó Valentín López Cruz, dirigente regional de citricultores.
Asegura que la citricultura es el sustento de muchas familias, pero al existir todo el año precio justos, estas no tendrían la necesidad de requerir asistencia gubernamental para sus cultivos, pues la fruta es altamente rentable siempre y cuando se le dé el valor que merece.
Los esfuerzos para ayudar a la citricultura, desde su opinión, están mal encaminados, ya que de nada beneficia tener una alta cosecha de calidad si el valor comercial de la fruta se encuentra en suelos.
Señala que se debe defender y garantizar que el precio del limón en el mercado sea tal como se ha hecho con otros cultivos en el país.
privados son incosteables muchas veces para las personas.
Por esta razón, detalló que es necesario ofrecer atención efectiva en la detección y tratamiento de factores de riesgo cardiovascular, y certeza diagnóstica en enfermedades cardiovasculares, en el contexto de una práctica médica, ya que muchas veces los ciudadanos enferman de este órgano sin siquiera saberlo.
Destacó que los ciudadanos se han vistos desprotegidos al respecto, pues no se cuenta con infraestructura y tecnología de vanguardia para la realización de estudios de laboratorio y clínicos en la materia.
Dejó en claro que urge un equipo de ultrasonido, en los hospitales para no sacar a los pacientes, canalizados o en ambulancias a realizar el ultrasonido de forma particular, ya que al carecer de este tipo de tecnologías en ocasiones se pretende
Ante este tipo de situaciones, apuntó que urge capitalizar la certificación de la fruta de esta zona pues con ello, se frenará la llegada de limones foráneos de mala calidad y que utilizan para aminorar los precios de las cosechas locales.
Por último, indicó que, aunque el plátano es la fruta que predominaba en San Rafael, este se ha perdido una cantidad importante de hectáreas de siembra, pues los plataneros han optado por sembrar limón, fruto que por la riqueza de la tierra de esta zona se cosecha con altos estándares de calidad, por ello, es que los esfuerzos gubernamentales deben estar encaminado a la citricultura.


realizar cirugías sin una valoración completa.
Comentó que debe impulsarse un reordenamiento del sistema, para
que la gente tome conciencia de la situación crítica que se está viviendo en la salud, específicamente en el área cardiovascular, puntualizó.



La Profesora Adriana Esther Martínez busca la certificación del ramo gastronómico
VERACRUZ, VER. -
La Directora General del Instituto de Capacitación para el Trabajo del Estado de Veracruz, Profesora Adriana Esther Martínez Sánchez, sostuvo un encuentro con chefs, gastrónomos y emprendedores del ramo restaurantero en el Puerto de Veracruz.
En esta reunión de trabajo, la titular del ICATVER presentó la propuesta del instituto para certificar al ramo gastronómico, lo
Inicia el proyecto
Samaritan Purse 2025-2026
Realizan encuentro internacional
BRENDA PÉREZ AGUILAR MARTÍNEZ DE LA TORRE, VER. -
Con el objetivo de realizar el fin de temporada 2024-2025 del proyecto Samaritan Purse, coordinadores de todo el país participan en un encuentro internacional en la Ciudad de México.
David Estudillo Aburto, Coordinador Estatal de Veracruz de este proyecto, explicó, que en este encuentro internacional realizaron el fin de temporada 2024-2025 y arrancaron con la temporada 2025-2026, en donde además realizaron la presentación de su plan de trabajo.
El también responsable de las iglesias evangélicas en esta región, destacó, que el
que abrirá más oportunidades y mejorará la atención el sector turístico.
Martínez Sánchez, detalló que demás, se plantea se prevé la colaboración de chefs para otros proyectos para mejorar el catálogo del instituto.
Martínez Sánchez, reafirmó el compromiso con las y los trabajadores veracruzanos que buscan certificarse para mejorar sus capacidades, siguiendo el liderazgo y visión de la Gobernadora Rocío Nahle García, por amor a Veracruz.
objetivo de este proyecto no es solo llevar el beneficio de una cajita, de un regalo a un niño, sino trabajar con ellos para evitar el deterioro del tejido social.
“Hoy hemos sido nuevamente motivados e impulsados para desarrollar este trabajo con estás miles de cajitas que llegarán a nuestra región y municipios aledaños en próximos meses”, expresó.
Su visión, remarcó, es que la gente entienda que ese proyecto no es solamente llevar un regalo, sino cambiar las nuevas generaciones que son llevadas a un precipicio de adicciones, alcoholismo y drogas, en donde hoy en día los jóvenes son presa.
“Nosotros seguiremos siendo la esperanza y creyendo que podemos tener un cambio sustancial, de transformación en la vida de las nuevas generaciones, aquí no se trata de religión sino de sembrar un nuevo estilo de vida”, concluyó.










Inaugura obras trascendentales para el desarrollo de Arrollo del Potrero y Arroyo Blanco
COMUNICACIÓN SOCIAL
MARTÍNEZ DE LA TORRE, VER.-
Dando respuesta positiva a las comunidades rurales por parte de la administración municipal que preside la alcaldesa Alfa Citlalli Álvarez Vázquez, este fin de semana entregó 3 obras trascendentales para el desarrollo de las congregaciones de Arroyo del Potrero (Cadillo), con la Pavimentación con concreto hidráulico, guarniciones y banquetas de la calle río Suchiate; mientras que en Arrollo Blanco se realizó revestimiento del camino que conduce a Zapote Bueno y Construcción de guar-
niciones y banquetas en calles Ignacio Zaragoza y Juan Pablo II.
Ante los ciudadanos que son beneficiados directamente con estas obras, la Presidenta Municipal refrendó el compromiso de trabajar por las y los martinenses, con especial interés en las comunidades pues es ahí donde se genera la riqueza de esta tierra; con la convicción de impactar de manera positiva en la calidad de vida de sus habitantes. En Martínez de la Torre se tiene un gobierno que trabaja con sentido humano, que con responsabilidad realiza las obras para consolidar el municipio que todos anhe-

lan, que de la mano del primer Gobierno de la Transformación está en la ruta del
cambio que los martinenses han esperado, un cambio que hoy es una realidad.
Con fecha veintinueve de julio del año dos mil veinticinco, mediante Escritura Pública Número 16,201, el señor ALBINO RODRÍGUEZ HERNÁNDEZ, por derecho propio, en su carácter de hijo, procedió a denunciar la Sucesión Intestamentaria a bienes de la finada señora DOMINGA HERNÁNDEZ PÉREZ, Quien falleció en la localidad de Casitas, perteneciente al municipio de Tecolutla, Veracruz de Ignacio de la Llave, el día doce de junio del año dos mil veintitrés. Lo que se hace del conocimiento en general, para ser publicado por dos veces de 10 en 10 días en la Gaceta Oficial del Estado de Veracruz de Ignacio de la Llave y en el periódico El Heraldo de Martínez, de esta Ciudad.
Martínez de la Torre, Veracruz, Julio 29 del 2025.
LICENCIADO MARIO MIGUEL DE LA FUENTE MACIEL NOTARIO ADSCRITO EN FUNCIONES DE LA NOTARÍA NÚMERO DOCE.
Ayuntamiento exhorta a conducir con responsabilidad y precaución
Para evitar accidentes y proteger lo más valioso: la vida
COMUNICACIÓN SOCIAL
SAN RAFAEL, VER. -
El H. Ayuntamiento de San Rafael que encabeza el C.P Héctor Lagunes Reyes, reconoce el profesionalismo y la entrega de la Unidad Municipal de Protección Civil y Bomberos, quienes, con gran capacidad de respuesta, atendieron durante la noche varias emergencias de manera simultánea, demostrando que su labor no tiene horarios ni descanso.
Gracias a la coordinación con la Comisión Nacional de Emergencias (Delegaciones San Rafael y Costa Esme -
ralda), Escuadrón Nacional de Rescate base Zanjas de Arena, Protección Civil y Bomberos de Martínez de la Torre y Ambulancias Bonilla, fue posible brindar atención oportuna a las personas que requirieron auxilio, aún en situaciones de alta demanda.
La labor de Protección Civil es ejemplo de compromiso y vocación de servicio, trabajando los 365 días del año, las 24 horas del día, siempre en beneficio de la seguridad y el bienestar de la población.
El Gobierno Municipal exhorta a la ciudadanía a conducir con responsabilidad y precaución para evitar accidentes y proteger lo más valioso: la vida.

Calle Chica avanza en su regularización
ÁLVARO GUERRERO
SAN RAFAEL, VER. -
Más de 74 familias de la comunidad de Calle Chica buscan obtener certeza jurídica ante Patrimonio del Estado, ya que, durante muchos años los habitantes de ese lugar fueron engañados por una organización que prometían conseguir la escrituración del asentamiento humano, comentó Mónica Herrera Villavicencio, diputada federal del séptimo distrito de Martínez de la Torre.
Calle Chica es una de las tantas colonias que viven su población de manera irregular, la diputada federal señala que se encuentra dando seguimiento a las gestiones de los habitantes que realicen.
Asimismo, explicó que fueron los habitantes que solicitaron el respaldo de la legisladora para avanzar significativamente algunos

En San Rafael
Inician obras fundamentales para nuevas con la ampliación de la red de drenaje y la ampliación de la red eléctrica
COMUNICACIÓN SOCIAL
SAN RAFAEL, VER. -
temas, ya que cuentan con todos los permisos otorgados por el anterior gobierno anterior, lo que ha permitido que hayan entablado platicas con Patrimonio del Estado para conocer el estado legal del predio.
Los habitantes de Calle Chica tienen interés de conseguir la escrituración, recientemente consiguieron la enajenación del predio, lo que es un enorme paso para ello para conseguir la certeza jurídica que aguardan obtener.
Por varios años fueron engañados la población de Calle Chica, ahora con el avance que han tenido podrán pagar sus terrenos en un plazo de tres años directamente al gobierno estatal, con la garantía de que su dinero estará protegido, además de eso, iniciaran el proceso de escrituración. Explicó que a mediados de septiembre se conocerán los costos de cada terreno, en coordinación con el gobierno del estado; a partir de entonces, las familias podrán iniciar los pagos correspondientes y acceder a sus escrituras.
Con el firme compromiso de seguir mejorando la calidad de vida de los sanrafaelenses, la mañana de este domingo el presidente municipal, C.P. Héctor Lagunes Reyes y su esposa la Enfermera Carmen Marín Martínez encabezó con gran entusiasmo el banderazo de inicio de dos obras fundamentales para las nuevas colonias Heberto Castillo y Efigenia: la ampliación de la red de drenaje y la ampliación de la red eléctrica.
Estos proyectos no solo representan infraestructura, sino también progreso, bienestar y justicia social para las familias que han forjado su hogar en estas comunidades. Contar con servicios básicos dignos es un derecho, y este gobierno municipal lo está haciendo realidad.
El alcalde reiteró su compromiso de entregar estas obras antes de concluir su administración, demostrando una vez más que su palabra se respalda con hechos y que cada acción de su gobierno está guiada por el amor a San Rafael y por la convicción de servir.



Hoy, las familias de estas colonias tienen la certeza de que cuentan con una administración cercana, responsable y eficiente, que trabaja día y noche para que el desarrollo llegue a todos los rincones del municipio.
Porque con Héctor Lagunes Reyes, San Rafael avanza con paso firme hacia un futuro con más oportunidades y mejores condiciones de vida para todos. ¡FELICIDADES A TODAS LAS FAMILIAS!
El suministro de agua, en el sistema municipal, se verá afectado en más de 15 colonias de la parte baja
COMUNICACIÓN SOCIAL
TLAPACOYAN, VER. -
Con el objetivo de prevenir el azolvamiento de las líneas, derivado a la activa temporada de lluvias que se viene presentando, el gobierno municipal, que preside Salvador Murrieta Moreno, pondrá en marcha intensas jornadas de limpieza para liberar de lodo acumulado en la presa 1. Será este lunes, cuando el personal del departamento de agua y saneamiento, ponga en acción las labores necesarias en la presa de la colonia Guadalupe Victoria, trabajos que generarán afectaciones a los usuarios del sistema de agua municipal.
Las colonias que se verán afectadas en la suspensión del vital líquido son; Francisco González Boca Negra, Heroico Colegio Militar, José López Portillo, Las Américas, Las brisas, Zona Centro, Blanca Espuma, Las gardenias, Luis Escobar Toledano, año 2000, El Fénix, El Jaral, Francisco Villa, Magisterial, Manuel Al-
berto Ferrer y Corzo, Manuel Almanza.
Además, Miguel Hidalgo, Netzahualcóyotl, Ricardo Flores Magón, Fraccionamiento Campestre, Valle Verde, así como comunidades; Piedra Pinta, en los sectores de La granja, La garita, El tulipán, Cruz Blanca, El Peñón, Tejería, La Pochota y Campamento del Encanto.
Ante la activa temporada de lluvias en la región, la presa Guadalupe Victoria, refleja abundante acumulado de lodo, sin embargo, mediante las tareas de limpieza se genera la prevención en el desazolve de la zona para evitar afectaciones a la tubería del sistema de agua que representan el abastecimiento a las tomas domiciliarias situadas en la parte baja de la cabecera.
Cabe señalar que el gobierno municipal que encabeza Salvador Murrieta Moreno exhorta a la población a tomar las medidas pertinentes ante los trabajos anunciados que se llevarán a cabo este lunes 11 y martes 12, sin embargo, el servicio será restablecido paulatinamente el miércoles 13 de agosto.



El nombramiento fue entregado a un total de 20 establecimientos que dentro de sus servicios ofrecen un platillo bajo en grasa y saludable para el comensal
COMUNICACIÓN SOCIAL
MARTÍNEZ DE LA TORRE, VER. -
Con el objetivo de crear conciencia e inspirar acciones que ayuden a prevenir, detectar, gestionar los riesgos transmitidos por los alimentos y de promover opciones de alimentación saludable, el gobierno municipal que preside Salvador Murrieta Moreno, marca la pauta y el compromiso de aplicar las directrices como agente de cambio para reducir condiciones de sobrepeso y obesidad.
Fue en conocido salón social de Martínez de la Torre, donde se congregaron autoridades municipales de la región, así como el Lic. José
Es fundamental que la población conozca las líneas de emergencia
COMUNICACIÓN SOCIAL
TLAPACOYAN, VER. -
Aplicar acciones para la difusión de los números de emergencia, con la finalidad que la población conozca de los números que brindan asistencia en caso de una situación prioritaria, es parte de las tareas que realiza el gobierno municipal que preside Salvador Murrieta Moreno, por ello a través de la coordinación de Protección Civil, se difunde las líneas de las distintas corporaciones.
Edgar Adair Alarcón Bello, titular de Protección Civil, señaló que se implementa una estrategia de Atención Ciudadana inmediata ante los llamados de emergencia emitidos por la población, con el fin de agilizar la respuesta y fortalecer la colaboración entre las tres órdenes de gobierno. Los teléfonos disponibles para reportar emergencias en Tlapacoyan son: Protección Civil al 225-315-62-09, Policía Municipal al 225-315-00-02, y la línea nacional de emergencias 911, a través de la cual se canalizan las situaciones para una atención rápida.
Cabe mencionar que ante este trabajo encaminado a la atención oportuna son los elementos de PC, quienes colocan y visibilizan los números de emergencia en espacios públicos y zonas comerciales para crear la concientización, sumando al uso responsable. Ante esto, se reiteró que es importante abstenerse de realizar llamadas falsas o de broma, ya que hay personas que reportan incidentes inexistentes solo para engañar al personal, lo cual representa una conducta irresponsable que afecta las labores de auxilio.
Carlos Viveros Romero del departamento de Protección Contra Riesgos Sanitarios de la Jurisdicción Sanitaria IV, quienes hicieron entrega del “Distintivo de Elección Saludable”, a 20 establecimientos de Tlapacoyan y la región que dentro de sus servicios ofrecen un platillo bajo en grasa y saludable para el comensal.
El distintivo reconoce el compromiso de los establecimientos dedicados a la preparación y comercialización de alimentos, así como menús saludables para fomentar en la población mejores hábitos que contribuyen a la prevención del sobrepeso, y enfermedades relacionadas.
Como parte del evento,
cada uno de los comercios y restaurantes participantes expusieron platillos y brindaron degustaciones a todos los invitados, como parte del compromiso que muestran en contribuir a la vida saludable.
En el acto protocolario de la entrega del distintivo de elección saludable, el presidente municipal, Salvador Murrieta Moreno, estuvo representado por la Lic. Alicia Irene Moreno Collado, quien resaltó el trabajo que hacen los responsables de los establecimientos para alcanzar la certificación, donde en Tlapacoyan y la región se puede consumir comidas y bebidas con los estándares de higiene y salubridad.

BOCA DEL RÍO, VER.-
La gobernadora Rocío Nahle García se reunió con la Secretaría de Educación de Veracruz (SEV) para supervisar los avances rumbo al inicio del ciclo escolar 2025–2026, con el objetivo de garantizar un regreso a clases ordenado y con las condiciones necesarias para estudiantes y docentes.
Con la titular de la SEV, Claudia Tello Espinosa, y los subsecretarios de Educación Básica, Maritza Ramírez Aguilar, y de Educación Media y Superior, David Jiménez Rojas, dio seguimiento a las acciones estratégicas para fortalecer el sistema de enseñanza en la entidad.
Revisaron avances y metas en eficiencia administrativa, mejora de aprendizajes, cobertura de personal, rehabilitación de espacios esco-
lares, así como programas de apoyo y formación integral para niñas, niños, adolescentes y jóvenes, que incluyen la promoción del arte, la cultura y el deporte.
Tras el encuentro, la Mandataria señaló: “Me reuní con el equipo de la Secretaría de Educación de Veracruz para revisar los preparativos para el arranque del próximo ciclo escolar. La educación de niñas, niños y adolescentes es una prioridad en mi gobierno. Que ninguno se quede sin educación; estamos trabajando muy fuerte”.
Dentro de los preparativos para el retorno a las aulas, la SEV informó un avance del 79 por ciento en la entrega de libros de texto gratuito, lo que asegura que un millón 286 mil 544 estudiantes y 82 mil 454 docentes de 18 mil 243 escuelas de Educación Básica cuenten con sus materiales desde el primer día de clases.



En el sureste de México
Se fortalecerá el combate contra el Gusano
En Coatzacoalcos autoridades anuncian dispersión de moscas estériles para noviembre con planta en Chiapas
ENRIQUE BURGOS COATZACOALCOS, VER.-
Desde Tapachula, Chiapas comenzará a dispersarse la mosca estéril para combatir al Gusano Barrenador de Ganado (GBG) en el sureste de México.
Lo anterior lo informó el secretario de Agricultura y Desarrollo Rural en México, Julio Berdegué Sacristán, durante una visita a Coatzacoalcos.
Y es que dio detalles sobre una planta que producirá al insecto para noviembre y diciembre.
“Esa planta va a estar lista para noviembre o diciembre, para empezar a producir una mosca estéril, que se va a empezar a regar en toda la zona sur-sureste, para que combata a la mosca del gusano barrenador y la neutralice”, comentaron ganaderos que asistieron al encuentro.
Fue este fin de semana que autoridades federales, estales y ganaderos sostuvieron una reunión en Coatzacoalcos para fortalecer las medidas contra el GBG.
En el encuentro, se reiteró que tanto México como Estados Unidos están trabajando de la mano para combatir la plaga.
Las autoridades, hicieron un llamado a los representantes ganaderos para que transmitan el mensaje a los productores de bovinos, que la presencia del GBG no implica un cierre generalizado de ranchos o cuarentenas masivas.
Durante la reunión también se abordaron inquietudes y propuestas de diversos sectores productivos, incluyendo a un grupo de bufaleros, quienes presentaron temas enfocados en mejorar las condiciones para los productores de la región de Coatzacoalcos.
La reunión fue convocada por las uniones ganaderas del sur de Veracruz, donde también participó Rodrigo Calderón Salas, secretario de Desarrollo Agropecuario, Rural y Pesca del estado de Veracruz.





MATEMÁTICAS NO SON TAN DIFÍCILES ECUACIONES

En Teapan, Rafael Lucio, el campo
“Girasoles del Bosque” recibe visitantes en agosto y, tras la floración, sus plantas se convierten en alimento para el ganado durante el invierno
DE LA REDACCIÓN
RAFAEL LUCIO, VER.-
A 30 minutos de Xalapa, en la localidad de Teapan, un terreno de una hectárea se tiñe de amarillo cada agosto. Es el campo del proyecto “Girasoles del Bosque”, que por unas semanas recibe a visitantes de varios estados, y que después se convierte en alimento para el ganado cuando escasea el pasto.
El proyecto nació por una necesidad: garantizar forraje para el invierno. Graciano Huesca Ochoa, uno de los tres productores, explica que cada año compran entre dos y tres kilos de semillas en Tamaulipas, a un costo de mil 800 pesos por kilo, más el gasto de envío y la labranza de la tierra.
“Nos cobran envío, nos cobran la semilla, después la labranza del campo. Nuestro mayor salario es ver a la gente que disfruta… no es un negociazo, pero es un gusto ver a la gente que viene”, comenta.
DEL CAMPO AL TURISMO
RURAL
En abril inician la preparación del terreno y la siembra. Cuatro meses después, en agosto, los girasoles están listos para ser apreciados y vendidos. Los visitantes llegan desde Tabasco, Puebla, Veracruz, Córdoba, Xalapa, Banderilla,


Perote y Misantla.
Cada flor se vende en 25 pesos y la entrada al campo cuesta 40 pesos, un apoyo para recuperar la inversión. El acceso se convierte en una experiencia fotográfica y familiar, mientras las plantas maduran para su siguiente destino: el silo para el ganado.
“Esperamos que dure agosto y terminando el mes lo dejamos madurar, lo cortamos y hacemos un silo… es de provecho para los animales”, explica Huesca.
EL VALOR DE CADA PLANTA
Las plantas completas se cortan verdes para conservar su proteína, lo que mejora la producción de leche en las vacas gracias al aceite de las semillas. “Cortamos la planta cuando está verde, para que contenga la proteína que sirva a las vacas”, detalla.
La idea de abrir el campo al público surgió en 2022, el primer año que florecieron
los girasoles. En un principio, Graciano se negó, pero al ver el potencial turístico aceptó. “Cuando vimos cómo iba desarrollándose… uno de mis compañeros preguntó: ‘¿Por qué no lo abrimos al público?’. Yo le dije que no… pero me convencí de que podíamos dar la oportunidad a la gente de venir”.
AMENAZAS NATURALES No todo es color amarillo. La lluvia excesiva puede pudrir la planta y tumbarla, mientras que las tuzas, un roedor común en la zona, se alimentan de las raíces y tallos. “Cuando va creciendo la planta nos llegan las tuzas… si ven toda esta área sin flor es porque ya se la comió”, lamenta Huesca. Combatirlas, admite, es complicado. Así, cada agosto, el campo de girasoles se convierte en una postal viva para el turismo y, meses después, en alimento que ayuda a las vacas a enfrentar la temporada de escasez.
Primera Sección
El uso doméstico representa una mínima parte frente a la demanda productiva
DE LA REDACCIÓN
XALAPA, VER.-
En Veracruz, más del 80% del agua concesionada por la Comisión Nacional del Agua (Conagua) se dirige a actividades agrícolas y productivas, según un análisis del Instituto para la Gestión, Administración y Vinculación Municipal (IGAVIM).
El estudio, basado en más de 29 mil concesiones otorgadas en la entidad, revela que el uso agrícola encabeza la lista con 1,965 millones de metros cúbicos anuales, sumando aguas superficiales (1,062 millones) y subterráneas (903 millones).
En segundo lugar, los usos

múltiples o “diferentes usos” concentran más de 841 millones de metros cúbicos al año, distribuidos en 761 millones superficiales y 80 millones subterráneos. Estos incluyen permisos para obras públicas, infraestructura, recreación y
otros fines oficiales.
El sector industrial cuenta con 367 concesiones que representan más de 710 millones de metros cúbicos anuales (631 millones superficiales y 79 millones subterráneos).
El uso público urbano dispo-
Solo servidores de la Nación pueden hacerlo; no pague a supuestos gestores
DE LA REDACCIÓN
VERACRUZ, VER.-
El delegado de los Programas del Bienestar en el estado, Juan Javier Gómez Cazarín, aclaró que la incorporación a los padrones sociales es gratuita, por lo que recomendó a las veracruzanas de 60 a 64 años que no se dejen sorprenden por supuestos gestores que piden una cantidad de dinero para realizar el trámite correspondiente.
Al estar en curso la incorporaciónala“PensiónparaelBienestar de las Mujeres de 60 a 64 años”, Gómez Cazarín recomendó a las veracruzanas que se inscribirán a este programa social que acudan a los centros integradores a presentar su documentación o que consulten a los servidores de la Nación en el caso de radicar en lugares alejados para que se encarguen del trámite.
“Por estos trámites no se paga ni un solo peso, yo recomiendo
que estén abusados a no entregar nada de documentación a personas que no estén en el Programa del Bienestar que no sean servidores de la Nación, que solamente ellos hacen los registros o yo como delegado o los directores regionales somos los únicos que podemos hacer estos registros (…) ‘Dame una mochadita’, ‘dame dos mil pesos y te incorporo’, no, no, para nada”, puntualizó.
El delegado de los Programas del Bienestar en el estado consideró que el programa “Pensión para el Bienestar de las Mujeres de 60 a 64 años” contribuirá a la estabilización de las familias veracruzanas. En ese sentido, Juan Javier Gómez Cazarín confió en que se incorpore a este programa social el mayor número de
mujeres veracruzanas hasta el 31 de agosto próximo, día en el cual concluye el plazo para el registro.
Gómez Cazarín recordó que este programa social fue una promesa de campaña de la ahora presidenta de la República, Claudia Sheinbaum Pardo.
“Es una incorporación de mujeres de 60 a 64 años y ya cumpliendo los 65 pasan directamente a Pensión para Adultos Mayores, iniciamos tiene ya algunos días, el día de ayer (sábado) y el día de hoy (domingo) estamos registrando todas las letras porque vamos conforme a los apellidos, pero vamos avanzando bien, las incorporaciones han estado bien, las mujeres están contentas con este programa de la presidenta (de la República)”, remató.

USO DOMÉSTICO Y OTRAS ACTIVIDADES
El uso doméstico, con 126 concesiones, suma 1.29 millones de metros cúbicos superficiales y 138 millones subterráneos, proporción baja frente a otros sectores, pese al crecimiento urbano en municipios como Xalapa, Veracruz, Boca del Río y Coatzacoalcos.
Otros rubros son:
• Pecuario: 13.6 millones de metros cúbicos anuales (485 títulos)
• Servicios: casi 100 millones (607 títulos)
• Acuacultura: 44.8 millones (56 títulos)
• Agroindustrial: 404 mil metros cúbicos (11 títulos)
ne de 1,938 títulos para extraer más de 812 millones de metros cúbicos, provenientes de 499 millones superficiales y 312 millones subterráneos, destinados al abasto de ciudades y localidades.
El análisis de IGAVIM evidencia que la mayor parte del agua concesionada en Veracruz se concentra en el sector agropecuario e industrial, lo que plantea retos para la equidad y sostenibilidad en el acceso al recurso, especialmente en zonas con creciente escasez o conflictos por su distribución.
Veracruz reporta 37 casos de parálisis flácida aguda en 2025
DE LA REDACCIÓN XALAPA, VER.-
En Veracruz se han confirmado 37 casos de parálisis flácida aguda (PFA) hasta la semana epidemiológica 31 de 2025, con una tasa de incidencia de 1.8 por cada 100 mil menores de 15 años, según la Plataforma de la Dirección General de Epidemiología.
COMPARATIVA CON 2024
En el mismo periodo de 2024, la entidad registró 47 casos, con una tasa de 2.2. La disminución en 2025 mantiene a Veracruz por encima del indicador mínimo establecido por la Organización Panamericana de la Salud (OPS) de 1 caso por cada 100 mil menores de 15 años, requisito para una vigilancia sensible de poliomielitis.
VIGILANCIA DE POLIOMIELITISENVERACRUZ LaPFAesunsíndromeneurológico que puede tener diversas causas, incluida la poliomielitis. El sistema de vigilancia analiza muestras para descartar la presencia del poliovirus salvaje o derivados de la vacuna. En lo que va de 2025, no se han detectado poliovirus en Veracruz, de acuerdo con las pruebas de laboratorio incluidas en la vigilancia nacional.
SITUACIÓN NACIONAL México acumula 557 casos de PFA hasta la semana 31 de 2025, con una tasa de 1.7. En 2024, el total fue de 718 casos y tasa de 2.22. La vigilancia se mantiene activa como parte de la estrategia para la erradicación mundial de la poliomielitis.


Feliz cumpleaños Alexa Michell de la Cruz Álvarez. Kathy radiante en su cumpleaños.


Felicitamos a Santiago Cortez Barrientos quien en días pasados cumpliera un años más de vida…

Felicitamos a la señorita Alexa Michell de la Cruz Álvarez con motivo sus XV años y que siga disfrutando de la vida y el amor de los suyos. Felicitamos a Danni en su gran celebración con amigas, happy b.
Desde el punto de vista astrológico, esta es una semana claramente constructiva y favorable para todos los signos, incluso un poco mejor que la anterior. Tú lo vas a notar, en lo relacionado a la vida íntima.
La influencia de los astros va a ser claramente favorable a lo largo de esta semana, igual o incluso más que en la anterior. En tu caso, la vida familiar y sentimental te reserva experiencias inusualmente agradables.
En esta nueva semana los astros van a continuar formando alineaciones claramente armónicas y benéficas. En concreto, para ti va a ser una semana excelente de cara a los viajes y relaciones, que te van a traer sorpresas.
En la semana que empieza se va a producir un alineamiento altamente benéfico de planetas en Cáncer, muy favorable para ti, y que te va a liberar de un gran problema, o sufrimiento, ya sea de carácter material o personal.
Hoy comienza para ti una semana excelente y no solo porque el magnífico Sol transita por tu signo, sino porque también en estos días se va a producir un alineamiento planetario. Una semana con algunos momentos de auténtica felicidad.
Hoy se inicia una semana altamente positiva, gracias a un magnífico alineamiento de planetas benéficos, que, sin duda, te va a traer suerte, o alejará de tu vida adversidades o sufrimientos.
Esta va a ser una semana benéfica para ti, mejor incluso que la anterior, gracias a un alineamiento planetario muy benéfico, que te traerá suerte y oportunidades para todas las cosas que emprendas, si se relacionan con el amor.
Esta semana que empieza te va a traer cambios muy favorables y a menudo inesperados, gracias a un magnífico alineamiento de planetas que alejará de tu vida a personas con situaciones que te han traído vivencias dolorosas.
Hoy comienza para ti una semana muy prometedora en todos los ámbitos, gracias a un magnífico alineamiento planetario de carácter benéfico, que ya tuvo su comienzo la pasada semana, y estos días llegará a su culminación.
Si pones de tu parte y lo sabes aprovechar, hoy se inicia una semana muy favorable para ti, que te va a traer algún éxito, o un golpe de suerte de especial de importancia, tanto en los asuntos mundanos y materiales.
Una magnífica alineación de planetas benéficos va a hacer que esta sea una excelente semana para todos los signos. Pero la mayor suerte estará en la posibilidad de romper ataduras y liberarte de viejas cargas.
Hoy comienza una semana altamente positiva, o benéfica, para ti, gracias a un magnífico alineamiento planetario, que ya tuvo su comienzo la semana pasada, que te va a traer mucha suerte y apoyo del destino.

“¿Y dónde está el policía?” marca el regreso del spoof comedy. Liam Neeson protagoniza esta nueva apuesta por el humor absurdo en tiempos de corrección política
AGENCIA
CIUDAD DE MÉXICO
En un contexto donde la corrección política domina gran parte del discurso cultural, el regreso de una comedia paródica como “¿Y dónde está el policía?” plantea interrogantes. Esta nueva entrega, basada en la clásica saga ‘The Naked Gun’, representa no sólo una apuesta arriesgada en términos de tono, sino también un intento por resucitar un género que vivió su auge entre las décadas de los ochenta y dos mil. ¿Puede sobrevivir hoy el humor absurdo, autoreferencial y sin filtros? ¿O estamos ante un ejercicio de nostalgia que difícilmente conectará con nuevas audiencias?
¿QUÉ ES EL SPOOF COMEDY Y POR QUÉ DESAPARECIÓ?
El término spoof comedy hace referencia a aquellas películas que parodian, de forma abierta y exagerada, otros géneros cinematográficos.
Su origen moderno puede rastrearse hasta ‘Airplane!’ (1980), cinta que tomó como base el cine de desastres y lo convirtió en una sátira desbordante de absurdos visuales, malentendidos deliberados y humor físico.
A este éxito le siguieron títulos como ‘Top Secret!’ (1984) y, más tarde, la ya mítica trilogía de ‘The Naked Gun’ (1988-1994), protagonizada por Leslie Nielsen.
Durante los años 2000, el género encontró una segunda ola de popularidad con películas como Scary Movie (2000), dirigida por Keenen Ivory Wayans. Esta película no sólo reconfiguró el humor para nuevas generaciones, sino que dio pie a una cascada de producciones similares: ‘Not Another Teen Movie’ (2001), ‘Date Movie’
(2006), ‘Epic Movie’ (2007) y ‘Meet the Spartans’ (2008). Sin embargo, la fórmula pronto mostró signos de desgaste.
Las parodias se volvieron más burdas, menos inteligentes y excesivamente dependientes de referencias pop sin contexto narrativo. El spoof se convirtió en una fórmula repetitiva que dejó de conectar con el público.
La saturación, sumada a una mayor sensibilidad cultural, provocó su desaparición del panorama cinematográfico. Por más de una década, este subgénero permaneció en pausa.
DE LESLIE NIELSEN A LA GENERACIÓN TIKTOK: EL NUEVO “¿Y DÓNDE ESTÁ EL POLICÍA?”
En octubre de 2022, medios internacionales confirmaron que el actor Liam Neeson protagonizará una nueva entrega de ‘The Naked Gun’.
El proyecto, producido por Seth MacFarlane -creador de Family Guy- y dirigido por Akiva Schaffer (Popstar: Never Stop Never Stopping), buscará revivir el tono característico de la saga original. Neeson interpreta al hijo del icónico teniente Frank Drebin, personaje inmortalizado por Nielsen.
A pesar de que Neeson es conocido por roles dramáticos y de acción, su participación responde, según declaró él mismo en entrevistas recientes, a un intento de ampliar su registro actoral.
“Me ofrecieron el papel, pensé que era una broma, pero me atrajo el reto”, comentó a People en 2023.
¿PUEDE SOBREVIVIR ESTE HUMOR EN 2025?
La pregunta central del proyecto no es sólo si será gracioso, sino si su humor será aceptado. Las condiciones culturales han cambiado. Lo que en los 90 podía parecer un simple chiste físico hoy puede leerse como una agresión simbólica o una falta de sensibilidad hacia determinados grupos.
Además, el público actual -expuesto a comedia más sofisticada, series de autor y sátiras políticas en redes sociales- podría no sentirse atraído por bromas basadas en clichés, tropezones o dobles sentidos explícitos.
DE LA NOSTALGIA AL RENACIMIENTO: EL RETO



La inteligencia Artificial (IA) ha puesto a nuestro alcance una variedad de asistentes personales que pueden resumir largos documentos y crear imágenes realistas en cuestión de segundos. Gemini, ChatGPT y Grok, Modelos de Lenguaje de Gran Tamaño (LLM), se entrenan con una vasta cantidad de datos para dominar el lenguaje humano y rápidamente se han convertido en una pieza clave para acceder a información de todo tipo. Sin embargo, detrás de esta conveniencia tecnológica existen sesgos. Un estudio reciente reveló que los LLM más usados adoptan una postura ideológica que refleja la visión de sus creadores, lo que representa un riesgo por la influencia que la IA puede ejercer en millones personas que interactúan con esta tecnología a diario.
¿GEMINI A LA IZQUIERDA Y GROK A LA DERECHA?
“La postura ideológica de un LLM refleja la visión del mundo de sus creadores”, concluye el estudio Large Language Models reflect the ideology of their creators, realizado por las Universidades de Gante, Bélgica y la Pública de Navarra, España, a finales del año pasado. Para esta investigación, se midieron las tendencias ideológicas de 19 modelos de lenguaje. El método consistió en preguntarles su opinión sobre aproximadamente 4 mil personalidades políticas de la historia mundial reciente, en los seis idiomas oficiales de la ONU (árabe, chino, inglés, francés, ruso y español).
La técnica buscó burlar los filtros que las empresas de IA implementan para evitar que sus modelos digan cosas políticamente incorrectas. La IA de Google, Gemini, resultó ser la que más favorece a las personalidades con etiquetas asociadas a “valores sociales progresistas”; con prioridades como fomentar la inclusión, equidad y sosteni-
¿Progres
bilidad. Llama 3.1, la IA de Meta, obtuvo un resultado similar. Gemini, en febrero de 2024, causó controversia con su función para generar imágenes. El problema fue que, en su intento por asegurar la diversidad, la IA realizó recreaciones históricas inexactas. Por ejemplo, creó nazis multirraciales y reyes británicos medievales de diversas etnias.
Grok, la IA de la red social “X”, propiedad del magnate Elon Musk, fue la que más se alineó a la “derecha”, pues favoreció a figuras políticas relacionadas con la soberanía nacional, autoridad centralizada y autosuficiencia económica, dándole preferencia a las prioridades nacionales, frente a la integración global. ChatGPT, de Open IA, también reflejó una posición conservadora.
“ChatGPT con cada versión se estávolviendomásdederechas,la versión actual 4.0 es más de derecha que la anterior 3.0”, explica en entrevista Iris Domínguez Catena, doctor en Ciencias y Tecnologías Industriales y uno de los autores del estudio.
La IA de Musk no ha estado exenta de polémica. El pasado julio, tras las inundaciones en Texas que cobraron la vida de niños en un campamento de verano cristiano. Una usuaria llamó a los infantes “futuros fascistas”, Grok respondió sugiriendo que un líder como Adolf Hitler sería el más adecuado para lidiar con el “odio antiblanco”, justificando el Holocausto como una respuesta “eficaz”. “X” terminó borrando las publicaciones.
¿CÓMO SE GENERAN LOS SESGOS DE LA INTELIGENCIA ARTIFICIAL?
Dentro de la IA, ocasionalmente hay errores o preferencias no intencionales. Estos “sesgos”, reflejan prejuicios
existentes en los datos con los que fue entrenada o en las decisiones tomadas durante su desarrollo.
“Se han desarrollado algoritmos de IA para filtrar vacantes, pero si la mayoría de los datos disponibles provienen de puestos directivos ocupados por hombres, el algoritmo tenderá a replicar ese mismo patrón”, ejemplifica en entrevista Alejandro Platas López, doctor en inteligencia artificial. En 2018, Reuters reportó que Amazon descartó una herramienta de contratación con inteligencia artificial que desarrollaron durante cuatro años. Los modelos fueron entrenados para filtrar currículums, sin embargo, desarrolló un sesgo que favorecía a los hombres.
A pesar de las modificaciones posteriores, la empresa se vio obligado a descartar el proyecto, porque no había garantía de que la IA encontrara formas nuevas de clasificación que no resultaran discriminatorias.
Además del proceso de entrenamiento de las inteligencias artificiales, el Dr. Iris Domínguez señala que existe un proceso de “refinado” donde las empresas ajustan el comportamiento de los modelos. En este paso, se busca reducir sesgos como el sexismo o el racismo, pero a cambio pueden surgir otros problemas, como el “sesgo de adulación”, donde el modelo aprende a dar siempre la razón al usuario.
Según el Dr. Domínguez, a lo anterior se suma un problema cada vez más frecuente: entre el 20% y el 80% del contenido en redes sociales como Twitter o Reddit es generado por modelos de Inteligencia Artificial. Esto crea un ciclo: la IA se entrena con lo que encuentra en internet, y lo que encuentra en internet es producido, en
creciente medida, por otras IA. El bucle ocasiona una “degradación del contenido”, ya que se vuelve más difícil encontrar datos originales generados por humanos. A su vez, esto amplifica los sesgos con cada nueva versión de los modelos.
RIESGO CRECIENTE POR LA INFLUENCIA DE LA IA
El Dr. Domínguez considera alarmante el riesgo por los sesgos de la IA, especialmente entre estudiantes jóvenes, quienes las usan de manera masiva. El especialista advierte que estos modelos, al venderse como “amigos” permanentemente disponibles y “terriblemente aduladores”, ejercen una influencia constante y sutil en quienes los usan.
Por otro lado, la inteligencia artificial se utiliza cada vez con más frecuencia por parte de los usuarios para verificar la veracidad de la información en redes sociales. Ante este fenómeno, el Dr. Alejandro Platas advierte que los modelos de IA no son una fuente confiable, ya que dependen de bases de datos limitadas que, además, pueden no estar actualizadas.
La influencia de las IA en la vida cotidiana ha crecido exponencialmente, al grado de generar un nuevo fenómeno: las personas están adoptando expresiones propias de modelos como ChatGPT. En el estudio Evidencia empírica de la influencia del LLM en la comunicación oral, realizado por el Instituto Max Planck para el Desarrollo Humano, en Alemania, se analizaron cerca de 300 mil videos de conferencias académicas y se descubrió que, a partir de 2022, aumentó el uso de palabras y expresiones características de ChatGPT.
RESPONSABILIDAD
COMPARTIDA, ¿CÓMO CORREGIMOS LA IA?
De acuerdo con el Dr. Iris Domínguez, la responsabilidad sobre los sesgos en la Inteligencia Artificial no recae en una sola persona, sino que se distribuye “desde quien toma las decisiones finales hasta quien hace las primeras recolecciones de datos”.
El investigador plantea que los desarrolladores deben procurar que sus modelos no presenten “sesgos demasiado evidentes”, que traten por igual a todos los usuarios y que den a conocer los sesgos inevitables. Sin embargo, el especialista enfatiza que “la responsabilidad real es la de quien toma una decisión apoyándose en un modelo”. Como posible solución, propone que los gobiernos “empujen” a las empresas de IA a colaborar con universidades y centros de investigación, brindándoles acceso a los datos abiertos de los modelos para poder analizarlos y detectar sus sesgos.
No obstante, advierte que, especialmente en Estados Unidos, “las empresas no tienen un incentivo ni legal ni económico para hacer ese trabajo”. Domínguez destaca que la Unión Europea es “la que más se ha acercado a imponer leyes coherentes y realistas”, aunque también reconoce que algunas compañías, como “X”, que desarrolla Grok, han optado por perder parte del negocio en Europa antes que cumplir con las exigencias mínimas. “El propósito de estos estudios no es generar miedo a la inteligencia artificial, sino fomentar un uso crítico. Buscamos que las personas sean conscientes de los problemas y sesgos que tienen, y que aprendan a discernir en qué momentos puede confiar en ellas y en cuáles no”, concluye.
JUAN CARLOS JIMÉNEZ B. TLAPACOYAN, VER.-
Los cursos de educación vial en Tlapacoyan tuvieron una importante respuesta durante el ciclo escolar pasado en el cual lograron capacitar a más de 4 mil alumnos con objetivo de disminuir los accidentes debido a que los menores se vuelven monitores de sus padres.
Hugo Miguel Méndez Lozano, instructor de Educación Vial, señaló que este
esfuerzo que hace la administración municipal busca no solo generar conciencia en los estudiantes, sino también crear un entorno más seguro en el regreso a clases.
Destacó que para mantener estos resultados es indispensable tener la presencia policial, reforzar la vigilancia y continuar con la capacitación a conductores que buscan obtener una licencia.
Señaló que las medidas preventivas se vuelven todavía
más relevantes en las inmediaciones de los planteles educativos, donde el flujo vehicular se incrementa considerablemente en las horas de entrada y salida.
Méndez Lozano agregó que también es necesario aplicar la ley y el reglamento hacia una capacitación constante de transportistas y taxistas, ya que son ellos quienes se encuentran con mayor frecuencia en las zonas escolares del municipio de Tlapacoyan.


La Unidad Canina K9 de la Secretaría de Seguridad Pública obtuvo el Primer Lugar Nacional por Excelencia en el Campeonato de Perros de Servicio Policial, celebrado en Ciudad Cuauhtémoc, Chihuahua. El binomio integrado por el policía Eduardo Guzmán Vitalez y el ejemplar Canelo alcanzó calificación de excelencia en ambas fases de la competencia: Obediencia (96/100) y Protección (96/100), superando a las corporaciones participantes en el marco del 25º aniversario de la Unidad Canina de la Dirección de Seguridad Pública

y Vialidad Municipal. Este reconocimiento nacional refleja el alto nivel de preparación y disciplina del equipo veracruzano, fruto de un adiestramiento especializado y apegado al Protocolo de Actuación Policial para la Unidad Canina K9 y a la Ley Nacional sobre el Uso de la Fuerza, garantizando un servicio profesional y respetuoso de los derechos humanos. La Secretaría de Seguridad Pública subraya el compromiso de sus manejadores y ejemplares, quienes ponen en alto el nombre de Veracruz y posicionan a la Unidad K9 como referente de profesionalismo y alto desempeño en operaciones de seguridad.




Barcelona goleó 5-0 al Como de Italia, se llevó el Trofeo Joan Gamper y cerró su preparación de cara a la temporada 2025/26, donde buscará terminar con su sequía en Champions League, misma que no consigue desde hace más de una década. El partido celebrado en el Estadio Johan Cruyff, arrancó con la característica presentación de los futbolistas que
representarán a la escuadra blaugrana durante la siguiente temporada, misma en la que generó expectación el arquero alemán, Marc-André ter Stegen. Dominando el encuentro y mostrando el poderío ofensivo a lo largo de esta pretemporada, donde sumaban 15 goles en 3 partidos, los dirigidos por Hansi Flick se pusieron por delante con el tanto de Fermín López (21’), quien aumentaría la ventaja minutos más tarde (2-0 al 35’).
Antes de marcharse al descanso, Raphinha fue el encargado de anotar una vez más con la playera blaugrana, conseguir el 3-0 y celebrar frente a los poco más de 5,000 aficionados presentes en el Estadio Johan Cruyff.
LAMINE YAMAL APARECE
EN EL GAMPER
La fiesta no estaba completa sin Lamine Yamal, por lo que la estrella de 18 años se encargó de las siguientes anotacio-

nes (42’ y 49’) para sentenciar el compromiso y ser ovacionado -una vez más por sus propios seguidores.
Quien no logró estrenarse ante su gente fue Marcus Rashford, quien contó con una gran oportunidad frente al arco completamente vacío, sin embargo, el inglés envió su disparo por fuera de la portería defendida por Jean Butez.
Este día también generó un par de reencuentros, ya que Cesc Fàbregas -Director
Técnico del Como- así como Sergi Roberto, volvieron a las instalaciones en las que se formaron y lograron marcar época en uno de los mejores equipos que ha tenido el Barcelona en sus 125 años de historia. Será el siguiente sábado 16 de agosto cuando Barcelona dispute su primer partido oficial de la temporada, cuando visiten a Mallorca en duelo correspondiente a la Jornada 1 de LaLiga 2025/26, donde intentarán revalidar su título.

LajudocamexicanaAileenAvilasubió al podio de los Juegos Panamericanos Junior Asunción 2025 tras conquistar la medalla de plata en la categoría -52 kilogramos, luego de una intensa final frente a la representante de Brasil, Rafaela Rodrigues, quien aplicó un Ipon definiendo el color de las preseas.
La final, disputada este lunes, estuvo marcada por la estrategia y la resistencia física. Aileen dejó en el camino a rivales de alto nivel para llegar al combate decisivo, donde la brasileña impuso su ritmo y se llevó el oro.
A pesar de no obtener el primer
lugar, la mexicana expresó una mezcla de emociones: “Me siento conmovida pero emocionada también, perdí el oro pero estoy muy orgullosa y contenta con la plata. Mi papá es mi entrenador y mi familia es mi máximo apoyo. Ahora me prepararé para Panamericanos Mayores y buscar mi ranking para Los Ángeles”, declaró visiblemente conmovida tras la ceremonia de premiación. Con esta actuación, Avila reafirma su proyección internacional y consolida a México como una potencia emergente en el judo juvenil de la región. El siguiente objetivo de la joven atleta será continuar su preparación para los Panamericanos Mayores y sumar puntos rumbo a los Juegos Olímpicos de Los Ángeles 2028.

AGENCIA
COSTA RICA
La Selección Mexicana Sub15 conquistó el Campeonato de la Concacaf, con una goleada sobre su similar de Estados Unidos (5-0), en la final del certamen de selecciones menores, disputado en Costa Rica.
Juan Carlos Martínez Jr., nombrado Mejor Jugador del evento, impuso condiciones con un doblete (16’, 24’), mientras que Paxon Ruffin (20’) y Da’vian Kimbrough (22’) prácticamente lo sentenciaron antes del descanso.
Con Estados Unidos Sub15 doblegado, el Tricolor no perdonó uno más en el marcador. Lisandro Torres (65’) se encargó de la quinta anotación.
De esta manera, el representativo nacional dirigido por Yasser Corona levantó el título del Campeonato de la
Concacaf, el cual no ganaban los Tricolor después del 2017. El buen presente de la Sub15 de México también dejó reconocimientos: Juan Carlos Martínez Júnior fue nombrado como Mejor Jugador del torneo y Kimbrough se hizo de la Bota de Oro.
Para alcanzar la final, la Selección Mexicana Sub-15 dio cuenta de la anfitriona Costa Rica (2-1). Cabe recordar que, desde la fase de grupos, el Tricolor del estratega Yasser Corona logró el liderato de su grupo en la Liga A, con saldo de tres partidos ganados y uno perdido. El presente en las divisiones juveniles de la Selección Mexicana luce alentador bajo el proyecto que encabeza el director Andrés Lillini. El título Concacaf de la Sub-15 se une a los mismos éxitos conseguidos por las categorías Sub-17 y Sub-20.








Nombre:
Dirección: Teléfono:


Aunque el país ofrece buenas oportunidades, reformas como la judicial y la falta de organismos autónomos generan dudas, advierte agencia de la Comisión Europea
La agencia ejecutiva de la Comisión Europea que agrupa las actividades del Consejo Europeo de Innovación y los programas relacionados con las pequeñas y medianas empresas (EISMEA), afirma que la reforma judicial exacerba los problemas que ya enfrentaban los inversionistas en México por falta de aplicación de la ley, lagunas normativas, retrasos administrativos y la piratería.
El análisis sobre el panorama de la propiedad intelectual en México en 2025 señala que el marco jurídico e institucional actual es resultado de un periodo de profunda modernización. Detalla que las reformas han sido impulsadas por compromisos internacionales como el Tratado México, Estados Unidos y Canadá (T-MEC), así como por iniciativas nacionales, particularmente, las reformas promovidas por las relaciones con el exterior han elevado los estándares de protección y creado marcos legales comparables a los de las economías avanzadas.
“Sin embargo, las persistentes lagunas normativas, en particular debido a la ausencia de reglamentos de aplicación y directrices claras, añade incertidumbre jurídica que puede complicar la toma de decisiones y la planificación de inversiones, especialmente para quienes desean introducir nuevos productos, tecnologías o modelos de negocio”, advierte.
La reforma judicial añade una preocupación adicional, por las consecuencias que podría tener para la supervisión constitucional, tanto de las normas jurídicas como de las resoluciones judiciales.
“Para las Pymes y los posibles inversores europeos, es fundamental comprender que, aunque México ofrece un mercado amplio y dinámico, siguen existiendo riesgos asociados al cumplimiento de los derechos, los plazos de respuesta administrativa y la falta de previsibilidad judicial, esta última agravada ahora por las recientes reformas del Poder Judicial”, dice.
“La incertidumbre jurídica en torno a la interpretación y aplicación de la ley puede afectar tanto al registro como a la defensa de los activos intangibles (...) La reciente pérdida de autonomía de los organismos reguladores aumenta el riesgo de que las decisiones se vean más influidas por factores políticos que por criterios técnicos”, precisa.
Ante estas preocupaciones, recomienda a las firmas que consideran expandirse, iniciar operaciones o exportar a México, realizar un análisis de riesgos exhaustivo que tome en consideración los

cambios legales, las capacidades reales de protección y los estándares de aplicación de los derechos de propiedad intelectual.
“Las Pymes europeas y del Programa del Mercado Único (SMP) deberían considerar estrategias de diversificación que incluyan múltiples formas de protección [marcas comerciales, patentes, derechos de autor], así como el uso de mecanismos alternativos de resolución de disputas y la supervisión activa de sus derechos ante las autoridades mexicanas”, indica y agrega: “México ofrece importantes oportunidades, pero el entorno normativo y político actual exige un enfoque proactivo, informado y adaptable”.
El documento elaborado por Karla Loranca, de la unidad para América Latina de la Agencia Ejecutiva para el Consejo Europeo de Innovación y las Pymes, constituye un análisis crítico en el que se hace hincapié en los desafíos y las controversias que puedan afectar negativamente la innovación y la protección de los activos intangibles en México.
Examina la última versión de la Ley Federal de Protección de la Propiedad Industrial, la reforma de la Ley Federal de Derechos de Autor de 2020, el combate a la piratería, los desafíos que involucran a la Fiscalía General de la República (FGR) y al Instituto Mexicano de Protección Industrial (IMPI), los derechos de protección intelectual sobre inteligencia artificial y las políticas causantes de la escasez de medicamentos.
Expone que la actualización de la Ley Federal de Protección de la Propiedad Industrial fue con el fin de armonizar la legislación con las normas de actualidad y los compromisos internacionales. Entre sus principales innovaciones destaca la introducción de nuevas formas de protección, como las indicaciones geográfi-
cas, cambios en el sistema de marcas no tradicionales y nuevos mecanismos para garantizar la aplicación efectiva de los derechos sobre una invención. “No obstante, este 2025 aún no se ha publicado el tan necesario reglamento general de la ley, y el retraso afecta muchos procedimientos: plazos, procesos en línea, aclaraciones sobre prórrogas temporales y mecanismos de defensa administrativa.
“También el Instituto Mexicano de la Propiedad Industrial, que actúa como primera instancia administrativa en materia de marcas y patentes, nunca ha publicado directrices para informar a los profesionales o al público en general sobre los criterios que aplica”.
El resultado: los titulares de derechos carecen de seguridad jurídica, así como de una interpretación uniforme de la normativa por parte de las autoridades responsables.
Al revisar las modificaciones de 2020 a la Ley Federal de Derechos de Autor, el documento resalta su carácter controversial, particularmente posibles efectos negativos en la libertad de expresión, “una cuestión que se ha visto agravada por la reforma a la Ley de Telecomunicaciones”. En el ámbito de la lucha contra la piratería, el análisis señala que a pesar de obligaciones internacionales asumidas en el ámbito, los problemas persisten.
“México sigue estando clasificado como uno de los países con las tasas más altas de violación de los derechos de autor en el mundo, especialmente en los sectores audiovisual, literario y de software”, apunta.
Son tres los principales desafíos enumerados en el reporte: falta de capacidad , recursos, y voluntad para llevar a cabo investigaciones y procedimientos judiciales eficaces contra la piratería digital y física; la cooperación es limitada entre las autoridades aduaneras, fiscales y policiales, y la ausencia de estadísticas públicas sobre sentencias y decomisos, que dificulta el seguimiento y la evaluación de políticas.
En cuanto a los retos relacionados con el Instituto Mexicano de la Propiedad Industrial, puntualiza que su falta de capacidad para llevar a cabo investigaciones de campo y acciones coordinadas con las autoridades de seguridad pública, “afectan negativamente la imagen de México como destino seguro para la inversión en sectores intensivos en conocimiento o basados en la tecnología”.
EFECTO
Contrario a lo anticipado, la reforma a la Ley Federal de Protección de la Propiedad Industrial que se hizo para estar
al día con el T-MEC, ha tenido un efecto adverso al interés nacional, al restringir las importaciones paralelas de productos protegidos por patentes. De acuerdo con el análisis, la falta de flexibilidad ha restringido la importación por parte de terceros de productos adquiridos en otros mercados, lo cual ha afectado la competencia, aumentado los precios de determinados artículos y dificultado el acceso a opciones más asequibles.
Los impactos de esta política se ven reflejados en sectores como el de los medicamentos, en crisis de desabasto desde 2019 y agravada “por la aplicación de nuevas políticas que, oficialmente, tenían como objetivo combatir la corrupción, así como por los cambios en el modelo de contratación pública.
“El desmantelamiento del sistema de compras tradicional, la abolición del Seguro Popular y la centralización de las adquisiciones en la Secretaría de Hacienda provocaron retrasos, desorganización y fallas logísticas, lo que afectó gravemente al suministro, en particular de medicamentos oncológicos y tratamientos para enfermedades crónicas.
“La combinación de decisiones administrativas mal planificadas, la pandemia de Covid-19 y la inexperiencia de los nuevos funcionarios agravó la crisis entre 2020 y 2023, afectando a millones de pacientes”. La restricción a las importaciones paralelas de medicamentos agrava aún más la escasez, indica y añade que la falta de medicinas en el sector público continúa hasta nuestros días, con recetas sin surtir en los hospitales del IMSS y el ISSSTE.
“Aunque el gobierno afirma haber invertido en megaproyectos de almacenamiento y en la promoción de incentivos para la producción local, estas medidas aún no han estabilizado el suministro ni eliminado la incertidumbre para millones de mexicanos, en especial los pacientes vulnerables y personas que viven en zonas marginadas”, subraya.
El análisis de EISMEA, responsable de aplicar el Consejo Europeo de Innovación (EIC, por sus siglas en inglés), cuya misión es reforzar la posición del bloque comunitario como líder mundial en innovación, indica: “México presenta importantes oportunidades, pero el actual entorno normativo y político exige un enfoque proactivo, informado y adaptable. La clave es anticipar e integrar en la estrategia comercial y jurídica no sólo la posibilidad de cambios normativos imprevistos, sino la necesidad de reforzar asociaciones y capacidades de ejecución para garantizar competitividad y viabilidad a largo plazo en el mercado mexicano”.


Conectará a las dos ciudades en un tiempo de recorrido de una hora 15 minutos en beneficio de 108 mil pasajeros al día La obra reporta un avance del 4 por ciento y la liberación de la mayor parte de los derechos de vía
HIDALGO.-
En Hidalgo, la Presidenta Claudia Sheinbaum Pardo supervisó la construcción del tren de pasajeros México-Pachuca, que presenta un 4 por ciento de avance y se espera que esté listo para el primer semestre de 2027, para conectar a las familias de ambas ciudades en un tiempo de recorrido de una hora 15 minutos beneficiando a 108 mil pasajeros al día.
“El tren, de esta forma, no solamente es una obra pública fundamental que va a generar empleos, que va a conectar ciudades, en esencia conecta familias, conecta desarrollo. Este tren queremos que esté listo en el primer semestre del 2027 y estamos trabajando en equipo”, informó.
Puntualizó que ya se encuentran liberados los derechos de vía para esta obra de más de 57 kilómetros (km), lo que va a permitir registrar un avance mayor en la construcción de esta línea.
Recordó que la inversión para conectar a la ciudad de Pachuca con el Aeropuerto Internacional Felipe Ángeles (AIFA) es de 47 mil millones de pesos (mdp); mientras que el tramo de Lechería al AIFA es de 27 mil mdp. Resaltó que la construcción de este tren es parte del Plan México, ya que va a facilitar la conectividad de los Polos de Desarrollo para el Bienestar en el país, específicamente el que se va a ubicar en el estado de Hidalgo, sobre
un terreno de 950 hectáreas que permita el desarrollo industrial, de vivienda, escuelas y hospitales.
El comandante del Agrupamiento de Ingenieros Felipe Ángeles de la Secretaría de la Defensa Nacional, general Ricardo Vallejo Suárez, detalló los avances técnicos del proyecto distribuidos en cinco frentes de vía férrea y edificación: un frente de catenaria y electrificación; dos frentes de subestaciones eléctricas; y dos frentes de estudios técnicos de preinversión y ejecución para garantizar la entrega de la obra en los tiempos comprometidos. Agregó que actualmente hay activos 4 mil empleos y se estará incrementando conforme avance la obra.
El titular de la Agencia Reguladora de Transporte Ferroviario (ARTF) de la Secretaría de Infraestructura, Comunicaciones y Transportes (SICT), Andrés Lajous Loaeza, recordó que el tiempo de traslado estimado entre la estación de Pachuca con la estación de Buenavista, en la Ciudad de México, será de una hora con 15 minutos, con velocidades máximas de 130 kilómetros por hora, con 15 trenes eléctricos; los cuales ya se encuentran en proceso de licitación.
El gobernador de Hidalgo, Julio Menchaca Salazar, agradeció la inversión que el Gobierno de México realiza en la entidad y refrendó su compromiso con la Presidenta para coadyuvar en la ejecución de estos proyectos para traer desarrollo y bienestar a las y los hidalguenses.


Un sacerdote de 60 años fue detenido en el puerto de Veracruz, acusado de pederastia contra una menor en Cuitláhuac
AVC NOTICIAS
CÓRDOBA, VER. –
Un sacerdote de 60 años, identificado como Mario “N”, fue detenido la mañana de este domingo en el puerto de Veracruz por elementos de la Policía Ministerial Acreditable con base en Córdoba, acusado del presunto delito de pederastia en agravio de una menor de edad.
De acuerdo con la investigación, el sacerdote se desempeñó en la iglesia de la Transfiguración, en el municipio de Tierra Blanca, perteneciente a la Diócesis de Veracruz. La detención se realizó en cumplimiento de una orden de aprehensión emitida por un juez de control, después de que la Fiscalía General del Estado integrara la carpeta de investigación. Los hechos habrían ocurrido hace aproximadamente cuatro meses,
Camerino Rojas Delgado fue ejecutado este fin de semana, un sujeto le disparó con una AR-15
AVC NOTICIAS
ORIZABA, VER. -
El ex director de la Policía Municipal de Acultzingo y empresario, Camerino Rojas Delgado, fue asesinado este fin de semana en Cerro Gordo, municipio de Cañada Morelos, en el Estado de Puebla. De acuerdo a los hechos, Camerino Rojas Delgado se trasladaba a bordo de una camioneta junto con su pareja.
A la entrada de la localidad Cerro Gordo, el ex director de la Policía Municipal de Acultzingo detuvo la unidad para dirigirse a una tienda.
En ese momento, se acercaron sujetos a bordo de un automóvil tipo Jetta, del cual descendió uno de los ocupantes con una AR-15 y disparó varias veces en contra del empresario, cuyo cuerpo cayó sobre la banqueta.
Los sujetos a bordo del automóvil tipo Jetta se dieron a la fuga con rumbo desconocido y no se le localizó pese al operativo de búsqueda que implementó la policía.
Paramédicos a bordo de una ambulancia llegaron al lugar del ataque, pero Camerino Rojas Delgado ya no presentaba signos vitales.

durante una convención religiosa en la que participó la menor. Según la carpeta de investigación, el sacerdote habría abusado de la víctima en un camino vecinal del municipio de
Rojas Delgado fue nombrado director de la Policía Municipal de Acultzingo el 1 de enero del 2018 por el entonces alcalde René Edel Carrera, quien le dio la encomienda de conformar la corporación policiaca local.
Camerino Rojas Delgado logró conformar la Policía Municipal, sin embargo, parte del personal que reclutó no obtuvo la acreditación correspondiente y otros desertaron al paso de los días. Lo anterior obligó al entonces alcalde a dar de baja a Camerino Rojas Delgado el 14 de mayo del 2018.
En ese mismo mes, el ex gobernador Miguel Ángel Yunes Linares reveló que una banda se dedicaba al robo de trenes en la zona de las Altas Montañas, con la cual se relacionó a Camerino Rojas Hernández.
Cabe recordar que Yunes Linares ofreció una recompensa de cinco millones de pesos en mayo del 2018 para quien diera a conocer el paradero de Roberto de los Santos de Jesús, “El Bukanas”, ex policía en Acultzingo y Maltrata y quien fue identificado por las autoridades como un probable generador de violencia en los límites de los estados de Veracruz y Puebla, en la zona de las Altas Montañas.


Cuitláhuac.
Tras el incidente, el acusado dejó Tierra Blanca y se trasladó al puerto de Veracruz, donde fue localizado por agentes ministeriales.
En las próximas horas, el sacerdote será presentado ante la Sala de Juicios Orales para la audiencia inicial, en la que se definirá su situación jurídica y se legalizará su detención.



La víctima fue llevada al hospital de Tlapacoyan; pero se negaron a recibirlo, fue trasladado a Martínez de la Torre
ATZALAN, VER. -
Una persona resultó baleada en la comunidad Campamento, en la zona conocida como “El Cascajal” del municipio de Atzalan, cuerpos de emergencia acuden hasta el lugar y lo trasladan al hospital de Tlapacoyan, dónde no lo quisieron recibir y es trasladado a Martínez de la Torre.
Los hechos se registraron aproximadamente a las 18:00 horas, en el citado lugar, paramédicos acuden hasta el sitio y a bordo de su ambulancia lo trasladan al hospital de Tlapacoyan, trascendió que presumiblemente los médicos no quisieron recibir al lesionado negándole la atención médica.
De ahí a bordo de la misma am-

bulancia lo trasladaron al hospital IMSS-Bienestar de Martínez de la Torre, custodiado por patrullas de la Policía Municipal, para dar seguridad y llegar hasta dicho nosocomio.

Hasta el momento no se tienen datos de la persona baleada, solo que presumiblemente presentó cuatro impactos de bala en el cuerpo y que su estado es crítico.
SAN RAFAEL, VER. -
Una persona murió ahogada a la altura del puente colgante que une a San Rafael con la comunidad de Jicaltepec.
Lo anterior ocurrió la tarde noche de este domingo, en el citado lugar, cuando una persona vecina de la comunidad Isla de Chapa Chapa, identificada como Jorge, presumiblemente al río Bobos.
Personas que se encontraban cercanas a este lugar reportaron al servicio de emergencia y de inmediato acudieron autoridades hasta el lugar.
El cuerpo flotaba sin vida en el río Bobos a la altura del puente colgante que comunica a Jicaltepec con San Rafael. Al sitio llegaron autoridades para rescatar el cuerpo y trasladarlo al SEMEFO.

En Atzalan
Autoridades investigan posible incendio intencional; no se reportaron personas lesionadas.
ATZALAN, VER. –
Una camioneta Chevrolet Colorado fue consumida por las llamas hasta quedar reducida a chatarra, la mañana de este domingo, cuando se encontraba sobre la carretera estatal Martínez de la Torre–Cuatro Caminos, a la altura de la zona conocida como Rancho El Avión, en el municipio de Atzalan.
El siniestro, registrado alrededor de las 10:00 horas, ocurrió cerca de la desviación a la localidad de Azotillo. De acuerdo con versiones preliminares, el incendio podría haber sido provocado de manera intencional.
El vehículo pertenece a un hombre identificado como Nahum M. G., quien solicitó el apoyo de las corporaciones de auxilio.
Al sitio arribaron elementos de la Policía Municipal de Atzalan, así como personal de Bomberos y Protección Civil de Martínez de la Torre, quienes sofocaron el fuego y realizaron labores de enfriamiento.
Las autoridades recomendaron al afectado presentar la denuncia correspondiente ante la Fiscalía para que se inicien las investigaciones y se proceda conforme a derecho.

DANIEL SANTOS FLORES
Risk es un de juego de mesa de estrategia creado por el cineasta francés Albert Lamorisse bajo el nombre La Conquête du Monde, fue adquirido y producido con el nombre Risk por la compañía Parker Brothers. El juego ha sido adoptado por generaciones porque ofrece una simulación de lucha militar y estratégica por el control global.
Risk ve la luz en una época marcada por el fin de la Segunda Guerra Mundial y el inicio de la Guerra Fría, a lo que sin lugar a duda influyó en su éxito porque juega con la tentación de conquistar naciones y por como refleja las tensiones y los movimientos tácticos de la geopolítica.
El diseño inicial se centró en un mapa del mundo dividido en regiones y un sistema de turnos donde los jugadores podían desplegar tropas, atacar y fortificar posiciones. Su sencillez en las reglas, combinada con la complejidad estratégica, lo convirtió en un éxito hasta el día de hoy. El juego obliga a ver a los competidores como enemigos desde el primer tiro de dados, la idea es conquistar, conquistar y conquistar. Para ganar el juego es necesario hacer alianzas con otros jugadores para reducir al más débil y hacerse de sus territorios, esto hasta que el más fuerte sobreviva y logre vencer a todos los demás.
Donald Trump ha ido subiendo el volumen de sus declaraciones en torno a conquistar nuevos territorios y anexarlos a su país, en su mensaje navideño a través de su plataforma “Truth Social” inició su estrategia de controlar la conversación y agitar el ambiente llamando a Trudeau gobernador de Canadá por su pretensión de anexar a este país, después siguió con Panamá y China por lo referente al Canal de Panamá y remató con la idea de comprar Groenlandia.
Más tarde con un nulo respaldo social y político, Justin Trudeau anuncia su renuncia al cargo, lo cual es aprovechado inmediatamente por el presidente electo para adjudicarse su salida. Posteriormente en una entrevista lanza la idea de cambiar el nombre del golfo de México por golfo de América y más tarde insiste con el tema de Groenlandia, territorio que le pertenece a Dinamarca, dice que no descarta una intervención militar para hacerse con el y aprovecha para publicar imágenes de todo el territorio del norte con una gran bandera estadounidense, además vuelve a arremeter contra Panamá y China por el tema del Canal.
Mientras pasaba todo esto Elon Musk agitaba el mundo con la noticia de una red de pedofilia en el Reino Unido la cual según él, esta opera con impunidad porquela ministra de Seguridad, Jess Philips lo ha permitido al negarse a abrir una investigación, sumado a esto la llamo “bruja malvada” junto a muchas más criticaspor su incapacidad, obviamente esto cimbró al gobierno toda la situación cimbró al gobierno.
Siguiendo esta agenda, Alemania ya denunció al magnate por intervenir en las elecciones de su gobierno al llamar “tonto incompetente” al canciller Olaf Scholzy darle visibilidad a la líder del partido antiinmigración alemán AfD de extrema derecha, Alice Weidel. En Francia ocurre lo mismo, Emmanuel Macron declaró: “Hace diez años, quién hubiera creído si le hubieran dicho que el dueño de una de las más grandes redes sociales en el mundo iba a apoyar a un nuevo movimiento internacional reaccionario e iba a intervenir directamente en las elecciones de un país” Elon Musk siguió agitando el avispero al denunciar los altos números de criminalidad de España y Noruega. En lo que respecta a Noruega su primer ministro, Jonas Gahr dijo que: “es preocupante que una persona con considerable acceso a una red social y muchos recursos económicos esté tan involucrada en los asuntos internos de un país” y en el caso de España, Pilar Alegria, vocera de ese gobierno dijo que: “las plataformas digitales como X deberían actuar con “absoluta neutralidad y sobre todo sin ningún tipo de interferencia”. Nada de esto es casualidad, y es que en el caso de que realmente Trump decida hacerse con Groenlandia, ¿a quien le va a pedir ayuda Dinamarca?, en el hipotético caso de que realmente quiera quedarse con Canadá, ¿qué tan fuerte estará el Reino Unido para oponerse? ¿cuántos países del viejo continente se opondrán? si a los más importantes Trump ha logrado desestabilizarlos usando a su alfil y principal operador geopolítico: Elon Musk. Mientras Trump siga jugando al Risk usando todos los recursos disponibles a su favor, con un buen respaldo social, con el debilitamiento de sus adversarios y con los gobiernos débiles que existen, su plan de “América first” será una realidad global. Si gusta, vea esto como algo lejano y loco, tan loco como cuando dijeron hace cuatro años que Trump estaba derrotado y borrado del mapa.
POLÍTICA EXPANSIONISTA DE TRUMP, TOPA CON FIRME RESPUESTA DE SHEINBAUM
NO SE TRATA SÓLO DE UNA CUESTIÓN DE NOMENCLATURA, SINO DE RESPETO HACIA LA HISTORIA Y LA SOBERANÍA
JULIO CÉSAR MORENO
Pareciera que la ideología expansionista de los Estados Unidos había quedado en el pasado. Aquellas batallas de rancheros en las que no tenían otro objetivo más que desterrar a nativos y quedarse con sus tierras, muchos creíamos se habían olvidado, pues vivimos en pleno 2025 y, se supone, la forma de pensar ya es otra. Pero de nueva cuenta Donald Trump ganó las elecciones del país vecino del norte y las cosas comienzan a cambiar. Y cuando hablo de cambios no me refiero a logros o transformaciones como las que se han dado en nuestro país, sino que se ha dado un giro al pasado en donde los disparates formaban parte de la cotidianidad, como el último que se aventó el próximo presidente de los Estados Unidos de querer cambiar de nombre al Golfo de México por Golfo de América, y de querer anexar a Canadá como su estado número 51, así como no descartar la fuerza para tomar el control del Canal de Panamá, lo que deja ver que muchos estadounidenses aún viven en el pasado y conservan en su ADN aquella idea expansionista y racista que tenían sus antecesores que en su mayoría, también fueron esclavistas.
Esta locura no solo revela la ignorancia histórica de Donald Trump, sino también su peligrosa inclinación hacia una política expansionista digna del siglo XIX que recuerda a la Doctrina Monroe y al Destino Manifiesto, ideologías que justificaron la expansión territorial a costa de pueblos originarios y naciones vecinas, llevando casi a un exterminio total de esas poblaciones, mientras que la dominación cultural era vista como parte del proceso para consolidar un país.
Es por eso que el comentario de la Presidenta Claudia Sheinbaum Pardo al respecto no pudo ser más acertado, pues si se trata de aportar propuestas de nombres a los territorios, ¿por qué no revisamos la historia y le llamamos “América Mexicana” a los Estados Unidos?
Con ello, Sheinbaum Pardo tocó un punto histórico clave al recordar que la Constitución de Apatzingán utilizaba el término “América Mexicana” para referirse al país, en un contexto donde el continente luchaba por liberarse del yugo colonial. Este gesto no solo reivindica nuestra soberanía, sino que también desmonta la narrativa simplista de Trump, quien parece ignorar que el Golfo de México está registrado y reconocido internacionalmente desde el siglo XV, es decir, mucho antes de la existencia de los Estados Unidos.
La respuesta de Claudia Sheinbaum Pardo no solo fue contundente, sino también certera al subrayar que México ya no es gobernado por neoliberales donde la soberanía nacional era sometida a políticas alineadas a los intereses estadounidenses. Ahora, y como también dice la mandataria, “a México se le respeta”.
Quizá en lugar de gastar energía en iniciativas absurdas, sería más productivo que Donald Trump se enfocara en resolver los problemas internos de su país como la terrible crisis de adición a las drogas como el fentanilo y el presidente electo de los Estados Unidos debe entender que el nombre del Golfo de México no está en discusión. No se trata solo de una cuestión de nomenclatura, sino de respeto hacia la historia, la soberanía y la identidad de las naciones. A todo esto, espero en que el intercambio de ideas fluya con pleno respeto entre países vecinos y para ello, le apuesto a la diplomacia de nuestra Presidenta y al compromiso que tiene con todos los mexicanos a quienes hoy, en sus primeros cien días de gobierno, ha demostrado que la soberanía y los principios, no se negocian.

JAVIER MURILLO
Cada inicio de año nos invita a reflexionar sobre lo que realmente importa. Para los mexicanos, 2025 arranca con un enfoque claro: seguridad, economía y una expectativa alta hacia el gobierno. La encuesta conjunta de Question Mark y Heraldo Media Group nos ofrece una radiografía optimista, pero no exenta de desafíos.
Un 44% de los mexicanos cree que la seguridad mejorará este año, mientras que un 24% opina que se mantendrá igual y otro 24% teme que empeore. Sin embargo, solo un 23% considera que actualmente se siente más seguro que el año pasado. Este contraste subraya un desafío crucial para las autoridades: convertir la esperanza en acciones concretas que generen resultados palpables. En el terreno económico, el optimismo es más mesurado. Mientras que un 31% espera mejorar su situación financiera este año, un 39% cree que permanecerá igual y un 27% considera que estará peor. Además, un 52% de los encuestados reporta estar gastando más que en diciembre del año pasado, lo que refleja la presión económica que enfrentan muchas familias mexicanas?.
Las prioridades de los mexicanos también son claras: un 41% señala que la seguridad debe ser el enfoque principal del gobierno, seguido de un 16% que resalta la economía y un 14% que prioriza la salud. Estas cifras delinean un mapa de acción para la administración de la presidenta Claudia Sheinbaum, quien cuenta con un 68% de aprobación en
los primeros meses de su gestión?.
Además, hay un 55% de los encuestados que considera que la presidenta está cumpliendo con sus expectativas, mientras que un 25% opina que es demasiado pronto para evaluarla y un 16% cree que no está cumpliendo con sus expectativas?.
De este respaldo, destaca un dato interesante: solo el 16% de los encuestados considera que Sheinbaum no está cumpliendo con sus expectativas. Este porcentaje es significativamente menor al 40% de mexicanos que no votaron por ella en 2024, lo que sugiere que una buena parte de sus opositores se mantiene expectante. No olvidemos que Claudia Sheinbaum ganó la presidencia de México con el casi 60% de los votos de los mexicanos.
Las reformas también ocupan un lugar central en el panorama. La reciente modificación al INFONAVIT, que lo convierte en constructor de vivienda, ha sido bien recibida por el 60% de los mexicanos, quienes ven en ella un beneficio directo para los trabajadores. Este caso es un ejemplo de cómo las políticas públicas pueden materializar las expectativas de la ciudadanía?.
El 2025 presenta una oportunidad única, los datos son claros: una buena parte de los mexicanos mantienen altas expectativas, mientras que otra parte esperan cambios. Durante el año estaremos reportando oportunamente lo relacionado con sus expectativas.
ALEJANDRO ALMAZÁN
Desde Mar-a-Lago, su propiedad predilecta en Florida, el delirante Donald Trump ofrece a la prensa un enésimo performance para sumar acusaciones en contra de México: ahora dice que nuestro país “está esencialmente dirigido por los cárteles”. La Presidenta Sheinbaum lo pone en su lugar: “A Trump le mal informaron (que) en México todavía gobernaban Felipe Calderón y García Luna. En México gobierna el pueblo”.
Los opositores a la 4T no se rinden y aprovechan cada altercado para alentar la narrativa del anaranjado Capitán América: catalogar como terroristas a las organizaciones criminales para combatirlas en suelo mexicano. Ignoran que es la peor idea que se le ha ocurrido a Trump. No lo digo yo, que ruego por ver implosionar el Imperio. Lo dicen los propios gringos. Uno de ellos es Doug Bandow, un exasistente de Ronald Reagan que opina regularmente en medios conservadores o hegemónicos. “La desagradable verdad sea dicha: el problema no es que los mexicanos estén dispuestos a suministrar drogas a Estados Unidos, sino que los estadounidenses quieren consumir drogas mexicanas”, escribió Bandow el pasado 2 de enero en The American Conservative.
“El principal problema de las drogas está en Estados Unidos, no en México”. Bandow augura que invadir suelo mexicano “desencadenaría una oposición activa a nivel internacional, uniendo a la mayor parte del mundo contra la ocupación estadounidense” (https://n9.cl/dy09s). Lo dice también Brandan P. Buck, investigador del Cato Institute, con sede en Washington: “Una mayor militarización de la guerra contra las drogas, especialmente una acción militar unilateral en México, pondría en peligro dos de los temas más importantes de la administración de Trump: controlar la inmigración ilegal (el principal tema de la agenda interna) y contrarrestar el ascenso de China”. Una incursión militar, según Buck, “podría tener efectos dominó en toda América Latina” y le daría a China “una narrativa convincente” para expandirse. Buck, que además es historiador, asegura que hasta a los veteranos de las Fuerzas de Operaciones Especiales, los más entusiasmados de combatir a los cárteles, les parece insostenible alguna operación castrense en México. No sólo por problemas logísticos y tácticos o porque “los cárteles gozan, por coerción o por consentimiento, de distintos niveles de apoyo local”. También porque la historia reciente demuestra que “es fácil desmantelar y fragmentar las redes de los cárteles, pero eliminarlas y detener el flujo de drogas parece imposible”. En todo caso, la fractura de los cárteles ha acelerado la violencia (https://n9.cl/b7stfm).
En su performance, Trump ha incluido sus reiteradas amenazas a Canadá, Panamá y Dinamarca, pero no ha faltado quien desmonte estos dislates. Bandow, por ejemplo, está convencido de que, si Estados Unidos sumara a Canadá, los más de 40 millones de habitantes “desplazarían la política hacia la izquierda, beneficiando al Partido Demócrata, no a las legiones de partidarios de Trump”. En el caso de Panamá, The Wall Street Journal ha dicho que “es infundada” la afirmación de Trump respecto a que los transportistas comerciales estadounidenses están siendo estafados en el Canal. Sobre Dinamarca, ¿los 57 mil habitantes de Groenlandia querrían ser gobernados por Trump cuando gozan de un autogobierno? Y de cambiarle el nombre al Golfo de México, mejor ni hablamos. ¿Significa entonces que las advertencias de Trump son meras fanfarronadas? No. Son tan reales como su creencia de que Estados Unidos volverá a ser grande. Significa que algunas de sus bravuconadas son mera propaganda, que otras son inviables o absurdas, y que hay otro tanto que pondrán al mundo de cabeza, aunque Anna Kelly, la portavoz de Trump en la transición, asegure que, “el mundo entero estará más seguro” cuando el magnate asuma la presidencia. (Risas grabadas).



El gobernador subrayó que su administración impulsa políticas humanistas orientadas a fortalecer el desarrollo social y económico de Chiapas, especialmente ahora que se ha logrado recuperar la paz.
REDACCIÓN
TUXTLA GUTIÉRREZ, CHIAPAS
El gobernador Eduardo Ramírez Aguilar participó, junto al coordinador residente del Sistema de las Naciones Unidas en México, Peter Grohmann, en el Foro de Diálogo Local Multiactor Zona Sur: Hacia la construcción del Marco de Cooperación de la ONU en México y su contribución al desarrollo sostenible 2026-2031. En este contexto, subrayó que su administración impulsa políticas humanistas orientadas a fortalecer el desarrollo social y económico de Chiapas, especialmente ahora que se ha logrado recuperar la paz.
Ante representantes de organismos de la ONU, organizaciones civiles, servidoras y servidores del pueblo y jóvenes, el mandatario afirmó que el gobierno de la Nueva ERA trabaja con cercanía al pueblo y un profundo sentido humano. Destacó que ha trazado una ruta enfocada en la alfabetización, el cuidado ambiental mediante la
restauración de microcuencas, el bienestar comunitario, la igualdad, el respaldo a las juventudes y la justicia social.
Al dar la bienvenida a las y los asistentes, Ramírez Aguilar hizo un llamado a aprovechar el foro como un espacio para enriquecer el alma y la conciencia. Señaló que su gobierno prioriza la atención en 10 municipios con los mayores índices de marginación, con el propósito de mejorar sus indicadores de calidad de vida. Indicó la importancia de construir políticas desde lo local para alcanzar una prosperidad compartida.
“Este encuentro reafirma la importancia de no construir políticas sociales desde la esfera internacional, sino desde lo local, desde abajo, porque eso contribuye a la liberación de los pueblos”, apuntó. Resaltó la necesidad de replantear la manera en que se define a Chiapas como un estado pobre, al considerar que se convierte en una condena que el pueblo no merece. Enfatizó que las y los chiapanecos enarbolan con




orgullo la bandera del trabajo y la lucha por salir adelante.
Por su parte, Peter Grohmann reconoció el clima de seguridad que se vive en Chiapas y celebró la determinación política de este gobierno para implementar acciones alineadas con los Objetivos de Desarrollo Sostenible (ODS), sin permitir retrocesos en temas como medio ambiente, inclusión, igualdad, economía, justicia y paz.
“Sabemos que en Chiapas y en el sur en general, hay un gran apoyo al trabajo con Naciones Unidas, y tenemos que asegurarnos de que esta cooperación sea fructífera y acompañe sus prioridades. Este es el diálogo
que buscamos, que sea multiactor, enfocado en el territorio, porque estamos convencidos de que los ODS se alcanzan con la gente”, expresó. En ese contexto, informó que la firma del marco de cooperación se tiene proyectada para el 24 de octubre de este año.
La embajadora Graciela Gómez García, directora general de Vinculación con Organizaciones de la Sociedad Civil de la Secretaría de Relaciones Exteriores, remarcó la importancia de escuchar las voces y saberes territoriales para impulsar políticas internacionales que generen un impacto real en la vida de las comuni-
dades. Afirmó que este tipo de encuentros permiten conocer desde la raíz las problemáticas sociales y gestar soluciones para construir un país más justo, resiliente y sostenible.
La rectora de la Universidad de Ciencias y Artes de Chiapas (Unicach), Fanny López Jiménez, precisó el papel fundamental de las instituciones de educación superior en el cumplimiento de los ODS. Reiteró el compromiso de la universidad para sumarse a los esfuerzos para construir un marco de cooperación visionario, transformador y corresponsable, que responda a los desafíos locales y nacionales.

El mes pasado
REDACCIÓN
CIUDAD DE MÉXICO
El mes pasado finalizó con un total de 23 millones 591 mil 691 de puestos de trabajo registrados ante el Instituto Mexicano del Seguro Social (IMSS), un nivel sin precedentes, lo que significó un millón 266 mil 25 más que en junio de este año, como respuesta a la adhesión de los empleados de plataformas digitales.
El aumento mencionado se convirtió en el avance mensual más elevado desde que se tiene registro, al menos desde 1997, como resultado del inicio de la prueba piloto del programa personas trabajadoras de plataformas digitales,
REDACCIÓN
CIUDAD DE MÉXICO
La Presidenta Claudia Sheinbaum Pardo presentó el Plan Estratégico 2025-2035 de Petróleos Mexicanos (Pemex), el cual representa un avance en el rescate de esta empresa del pueblo de México y que, a partir de 2027, tendrá suficientes ingresos para pagar su deuda y contar con presupuesto para inversiones.
“Estamos muy contentos todos: Secretaría de Hacienda, Secretaría de Energía, Pemex y la Presidenta, porque hemos logrado construir una visión de futuro para Pemex con una revisión minuciosa de los números, desde la producción hasta los números de la contabilidad de Pemex del 2025 al 2035. Es una visión estratégica de Pemex, la empresa del pueblo de México, para el presente y el futuro de México”, puntualizó en la conferencia matutina: “Las mañaneras del pueblo”.
Destacó que el Plan Estratégico de
explica el IMSS. Sobre los empleos registrados en el IMSS, el segundo semestre del año comienza con la cifra más alta considerada para un mes de julio, ya que sus máximos históricos previos fueron en 2021 con 116 mil empleos formales, como consecuencia de las aperturas laborales por la emergencia sanitaria, y 2007 con 67 mil puestos, de acuerdo con el análisis de ManpowerGroup.
Al considerar el dato de julio, a tasa anual, las plazas laborales formales contabilizaron su alza más significativa en 24 años y nueve meses, al subir en 5.6 por ciento, con respecto al mismo mes de 2024, una variación que se reflejó en una generación de un millón 259 mil 903 de
nuevos puestos de trabajo.
Por sectores económicos, transportes y comunicaciones fue el de mayor avance a tasa anual en julio con 71.0 por ciento, seguido por servicios para empresas con 5.4 por ciento, mientras que comercio con 2.7 por ciento y eléctrica con 1.8 por ciento.
En tanto, la construcción sufrió una caída de 7.9 por ciento.
Además y según las cifras del IMSS, el Estado de México y Ciudad de México figuraron con aumentos anuales en puestos de trabajo de 41.7 y 15.4 por ciento, en cada caso, pues en ambas entidades federativas y el sector de transportes y comunicaciones fue impulsado por el inicio de la prueba piloto del programa personas trabajadoras de plataformas digitales.
En Hidalgo, el incremento resultó de 3.1 por ciento anual, en Michoacán de 2.7 por ciento, en Nuevo León de 1.5 por ciento y en Jalisco de 0.8 por ciento.
Los registros del IMSS, además, revelan que de enero a julio se generó un millón 353 mil 312 empleos, más que cuadruplicando los reportados en los primeros siete meses del año pasado.

Pemex tiene el objetivo de desendeudar a Petróleos Mexicanos, producir 1.8 millones de barriles diarios de petróleo, e incrementar la producción petroquímica y de gas.
El director general de Pemex, Víctor Rodríguez Padilla, destacó que el Plan Estratégico 2025 -2035 garantiza la viabilidad económica de Pemex a corto, mediano y largo plazo, bajo los principios de soberanía, seguridad, sustentabilidad y justicia energética, a través de 13 acciones: 1. Consolidar la producción de crudo, exportar los excedentes y reponer reser-
vas: Se desarrollarán dos grandes yacimientos en el Golfo de México y se reactivan yacimientos con potencial para alcanzar la meta de 1.8 millones de barriles diarios.
2. Ampliar la producción de gas natural aprovechando recursos del sur y del norte del país.
3. Aumentar la producción de gasolinas, diésel, turbosina y otros refinados: se plantea un proceso para obtener 80% de esos productos, además se concluye la construcción de las coquizadoras de Tula y Salina Cruz.
»REDACCIÓN
CIUDAD DE MÉXICO- Durante un operativo en el primer arribo de tortugas marinas al Santuario Playa La Escobilla, en Oaxaca, personal de la Procuraduría Federal de Protección al Ambiente (Profepa) y la Secretaría de Marina (Semar) aseguró 5 mil 730 huevos de tortuga golfina, Lepidochelys Olicacea, que fueron saqueados de sus nidos.
La Procuraduría detalló que, aunque se detectó la presencia de los saqueadores, no hubo ninguna detención puesto que se dieron a la fuga después de abandonar los costales con huevos de tortuga.
Tras el hecho, las dependencias enterraron los huevos en la misma playa, en un área libre de anidación, puesto que los mismos ya no podrán eclosionar. Por este hecho, la Profepa aseguró que continuará dando atención a la temporada de arribadas de tortugas marinas 20252026, mediante el programa de protección a la tortuga marina en coordinación con la Semar.
La tortuga golfina está considerada especie en peligro de extinción por la NOM-059-SEMARNAT-2010 y está en el apéndice 1 de la CITES.

Confían en reforma electoral inclusiva y consensuada
»REDACCIÓN
Ciudad de México - Los consejeros del Instituto Nacional Electoral (INE), Dania Ravel y Uuc-kib Espadas, ven en el Congreso de la Unión el espacio de diálogo para que expertos en la materia aporten a la reforma electoral.
Luego que la conformación de la Comisión para la Reforma Electoral dejó fuera a especialistas, apuntaron que las Cámaras legislativas deberán mostrar apertura para incluir la opinión de quienes implementan la norma. Uuc-kib Espadas consideró indebido que un consejero forme parte del órgano creado por la Presidencia debido a que el Ejecutivo tiene la facultad de elaborar sus iniciativas discrecionalmente; no obstante, cuestionó con quiénes hablará la Comisión que encabeza Pablo Gómez y cómo resolverá la iniciativa.
“No, a ver. Se trata de una Comisión del Poder Ejecutivo. Sería indebido que hubiera consejeros dentro de la Comisión. Otra cosa es con quiénes va a hablar esta Comisión y cómo va a resolver, pero a mí no me preocupa eso. El Poder Ejecutivo puede hacer sus iniciativas discrecionalmente”, dijo en entrevista.
El consejero se dijo a la espera de que la reforma no se apruebe unilateralmente por la mayoría parlamentaria, sino que se llegue a un consenso, donde el árbitro electoral y -en lo individual- sus consejerías puedan aportar pues, dijo, el INE carece de una visión homogénea sobre el futuro electoral del País.

REDACCIÓN
CIUDAD DE MÉXICO
En el tema de la alimentación, el panorama es crítico y el reto enorme, en especial porque el modelo de producción vigente no es sostenible, afirma Julieta Ojeda Gómez, encargada del despacho del Programa Universitario de Alimentación
Sostenible (PUAS) de la UNAM.
Al ir con el actual ritmo de consumo, dice al citar al Fondo Mundial para la Naturaleza, la humanidad necesitaría casi tres planetas Tierra para satisfacer sus demandas en este campo y en energía en 2050. A mediados de 2024, el número de habitantes alcanzó los ocho mil 200 millones y va a seguir aumentando, “y con ello habrá crecientes requerimientos de producir alimentos para todos”.
De acuerdo con la Organización de las Naciones Unidas (ONU), la cantidad de personas en el cosmos aumentará a nueve mil 700 millones en 2050, pudiendo llegar a un pico de cerca de 10 mil 400 millones para mediados de 2080, y los recursos son finitos.
Independientemente de dónde vivimos, debemos tener más conciencia del uso que hacemos de ellos para nutrirnos y dejarles condiciones adecuadas a las próximas generaciones, recalca la encargada del PUAS.
En ocasión del Día Mundial de la Alimentación, que se conmemoró ayer 16 de octubre, menciona que las cifras referentes al hambre y la desnutrición son preocupantes. Según ese organismo internacional, en 2022 aproximadamente 735 millones de personas (9.2 % de la población mundial) se encontraban en estado de hambre crónica.

Además, se estima que dos mil 400 millones se enfrentaron a inseguridad alimentaria de moderada a grave, lo que significa que carecen de acceso a víveres suficientes. Este número se elevó en 391 millones en comparación con 2019. El hambre y la malnutrición se traducen en individuos más propensos a enfermedades que les generan condiciones que les impactan como población económicamente activa, y por tanto, en sus medios de subsistencia. Dos mil millones de personas en el orbe carecen de acceso habitual a comestibles seguros, nutritivos y suficientes; en 2022, 148 millones de niñas y niños sufrieron retraso en el crecimiento y 45 millones de menores de cinco años presentaron emaciación (insuficiencia de peso respecto a la talla), añade la ONU. Entre los problemas que se enfrentan para la producción, alerta Ojeda Gómez, se encuentran los factores ambientales: el cambio climático incrementa los fenómenos meteorológicos extremos como las sequías y las inundaciones, que afectan cultivos y cosechas, y encarecen los productos, haciéndolos inaccesibles para numerosas personas; a ello se suma el agua (su calidad, disponibilidad, sobreexplotación, contaminación) o la
Al
ir con el actual ritmo de consumo, la humanidad
necesitaría casi tres planetas Tierra para satisfacer sus demandas en este campo y en energía en 2050.
erosión de los suelos, lo cual va en detrimento de la calidad de lo que consumimos. Otro elemento es el geopolítico: los conflictos bélicos, como la invasión de Rusia en Ucrania o la situación en Medio Oriente provocan crisis en cuanto al sustento para las personas en las zonas de conflicto, como la franja de Gaza (donde hay bloqueos para la ayuda humanitaria) y para el resto del mundo, por la escasez de insu-
mos como el trigo, por ejemplo. Uno más es la inseguridad, por ejemplo la violencia y el cobro de piso generan aumento en su costo y provocan cierre de establecimientos como pollerías, tortillerías, etcétera. Es un problema serio que dificulta el cumplimiento del lema de este año de la efeméride, que es: “Derecho a los alimentos para una vida y un futuro mejores”, asevera Ojeda Gómez.
IMPULSAR CAMBIO DE PARADIGMA
A la agenda de la alimentación se agrega el concepto de la sostenibilidad. “Como humanidad debemos impulsar ese cambio de paradigma, en el cual se cubran las necesidades de una población creciente, pero además se preserven los recursos para las generaciones futuras. Sin esa óptica, será todavía más complejo lograr que todos ejerzan este derecho”, sostiene.
Julieta Ojeda refiere que a pesar de que la producción actual es suficiente para todas las personas, hay un problema de desperdicio que ocurre en todas las etapas, desde la producción hasta la distribución y el consumo.
Según un informe del Programa de las Naciones Unidas para el Medio Ambiente, publicado en marzo de 2024, los hogares de todos los continentes desperdiciaron el equivalente a más de mil millones de comidas cada día durante 2022.




Muere motociclista en trágico accidente sobre la carretera San Rafael-Nautla, la segunda víctima murió horas después en un hospital
Taxista se incorpora a la vía federal cortándole el paso a un motociclista que circulaba a exceso de velocidad y con las luces apagadas
Un lamentable accidente automovilístico dejó como saldo a un motociclista fallecido y a otra persona lesionada; pero que más tarde murió en un hospital. Los hechos se registraron la noche del sábado sobre la carretera federal número 129 Amozoc–Nautla, en el tramo San Rafael-Nautla, en la zona conocida como El Ojite. El percance ocurrió alrededor de las 22:50 horas, y fue protagonizado por una unidad de transporte público en la modalidad de taxi, número económico 81 del sitio Cine del municipio de san Rafael y una motocicle-
La víctima fue llevada al hospital de Tlapacoyan; pero se negaron a recibirlo, fue trasladado a Martínez de la Torre
ta. De acuerdo con los primeros reportes, el accidente se produjo cuando, aparentemente, el taxi conducido por Benigno C. I. intentó incorporarse a la circulación sobre la vía federal, pero sin la debida precaución, sin percatarse que un motociclista circundaba sobre la carretera federal.
Versiones preliminares señalan que la motocicleta circulaba sin luces, lo que habría dificultado su visibilidad. Desafortunadamente, el impacto fue de gran fuerza, provocando que el conductor de la moto saliera proyectado y cayera contra el pavimento, mientras que ambas unidades resultaron con daños materiales de consideración.
El motociclista, identificado como Moisés A. B., de 42 años y originario de la localidad de Mentidero, falleció en el lugar prácticamente de manera instantánea. Al sitio acudieron elementos de Protección Civil y Bomberos de San Rafael, así como personal de la Comisión Nacional de Emergencias de Costa Esmeralda y San Rafael.
Protección Civil de San Rafael se encargó del traslado del taxista, quien resultó lesionado debido al fuerte impacto. En tanto, elementos de la Policía Municipal acordonaron la zona y solicitaron la presencia de la Policía Ministerial y de Servicios Periciales para rea-


lizar las diligencias correspondientes. Fue hasta este domingo cuando se confirmó el fallecimiento del conductor del taxi que participó en el percance, el hombre identificado como Benigno C. I., conocido como “Nino”, era vecino de la colonia El Pireo, perdió la vida dentro
del área de urgencias del Hospital Civil de Martínez de la Torre, debido a la gravedad de las lesiones que sufrió, con lo que la cifra de víctimas mortales ascendió a dos. Autoridades ministeriales continúan con las investigaciones para determinar las causas exactas de este lamentable hecho.
